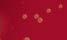
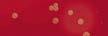
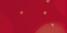

![]()




















































dit initiatief is mogelijk gemaakt door:








@pannenkoekdag




Op vrijdag 20 maart 2026 is het weer Nationale Pannenkoekdag, de 19e editie! We nodigen jouw school van harte uit mee te doen aan dit bijzondere evenement, waarbij basisscholieren in het hele land ouderen in het zonnetje zetten met zelfgebakken pannenkoeken.





Met de pannenkoekmixen van Koopmans maak je het vanzelf gezellig. Van meergranen tot een vleugje kaneel. Voor die momenten dat je samen bent.
























inmatchNAmeamade heaven...
I meant our organic lemon & ginger, but I like the way you think.
Uhm.. the birds and the bees?



12 TV-aso's
22 Society Journaal
28 Column Rob Goossens
60 7 vragen over de kinderopvang
64 DenD’s huwelijken
20 Hip & Hot
42 Koken met Sharon en wijnadvies van David
48 Op reis: Dublin
54 Eropuit
56 Sietskes Oogappels
68 In de Hoofdrol: Dinand Woesthoff
32 Huishoudbode
38 Groen geluk
76 Intiem met Lieve
82 Dierenwereld
86 Kits



82 Snuffelseizoen is geopend i s g eo p en d
















blik... en het escaleert


68 Dinand in The Voice, Lucy blijft dichtbij

7 VRAGEN AAN...




76 ‘Hij werd verliefd op mijn dronken versie’




60 Maria Rahman schreef over de kinderopvang ‘Het is een regime’ OP REIS



48 Dublin in 48 uur: pubs, bruggen en Guinness











SOCIETY


24








64 DenD-lezers TROTS op hun trouwfoto



Zo veroverde Zara ons land!
!




Elke maand meer dan 3,5 miljoen kijkers!



De Zweedse popster Zara Larsson maakt al bijna twintig jaar hits. Het is dus opmerkelijk dat ze dit jaar pas voor het eerst bij de Grammy’s aanwezig was. Niet als gast, maar als genomineerde voor Best Dance Pop Recording, dankzij Midnight Sun. In Nederland blijft vooral dat Ziggo Domemoment hangen met Julia Coster (16). Bij het nummer Lush Life trekt Zara iemand uit het publiek het podium op, en Julia kwam voorbereid. Ze hield een bord met ‘I KNOW THE DANCE’ omhoog, vrienden zetten haar met zaklampen in het licht. Zara zag het en Julia belandde in de spotlights.
Ondertussen draait op televisie de realityfabriek gewoon door. BN’ers hoppen al vijftien jaar van VIP-show naar BN’er-programma. Zet ze in een villa, op een boot, in een jungle of op een ‘therapy trip’ en binnen tien minuten heb je ruzie om niks, bondjes om nog minder, en daarna een foute quote. Bij pop hoor je een refrein, bij reality zie je bubbelbaden en teenzuigen. En ja, ik kijk zelf ook.
In deze DenD kun je alle kanten op. Van tuintips en een 48-uurs Dublin-guide tot Maria Rahman, die na jaren werken op verschillende crèches schrijft over de kinderopvang en met één zin blijft hangen: „Het is een regime.” Je krijgt ook trouwfoto’s van lezers en leest over Dinand in The Voice.
Anette de Vries











Zet
Wil jij ook op deze pagina verschijnen?
Stuur een e-mail naar: commercie@trustedmedia.nl
In hotels, restaurants en sportscholen zijn elektrische handdrogers al jaren normaal. Thuis pakken we nog steeds een handdoek of tissue. Tot nu: met de Palmz Handdroger brengt Quilo professionele handdroogtechnologie naar je interieur. Compact, stil en verrassend stijlvol. Hij is gebaseerd op professionele handdrogers: krachtige luchtstroom, snelle droogtijd, maar dan in een formaat dat prettig is voor dagelijks gebruik thuis. quilohome.com



Na het overdonderende succes van zijn bekroonde debuut Mijn stomme intenties, keert de jonge Italiaanse meesterverteller Bernardo Zannoni terug. Gero wordt over twee weken 25. Hij en zijn vrienden bevinden zich op een kantelpunt in hun leven, maar met dat leven weten ze zich geen raad. Juist als hij besluit het heft in eigen hand te nemen, dreigt het mis te gaan. In onvergetelijke scènes met een gele oppaspapegaai, een hoogzwangere buurvrouw en in een slachthuis betoont Zannoni zich niet alleen een intelligente, maar ook een buitengewoon grappige schrijver. deharmonie.nl




DenD geeft 10 exemplaren van 25 weg. Ga naar ditjesendatjes.nl/winnen om kans te maken.



DenD geeft 2 paar Rosé Quartz oorbellen van Roca de Piña weg. Ga naar ditjesendatjes.nl/ winnen.
Deze rozenkwarts oorbellen van roséverguld zilver zijn zacht van kleur en hebben een warme, romantische uitstraling. Ze zijn gemaakt om elke dag te dragen en worden met zorg verpakt. Roca de Piña verkoopt tijdloze sieraden, van subtiele oorbellen tot elegante kettingen met hanger, gemaakt van hoogwaardige materialen. rocadepina.com
JA! Instituut, de plek voor systemisch werk, lanceert JA! Luisteropstellingen. In twintig tot veertig minuten luister je, gewoon thuis of tijdens een wandeling, en krijg je meer zicht op patronen rond thema’s als familie, relaties, geld en keuzes. Een rustige, veilige manier om te zien wat van jou is, en zo meer inzicht en ruimte te krijgen in je leven. Er zijn zes thema’s. ja-instituut.nl
WINNEN!

DenD verloot 3 JA! Luisteropstellingen. Ga naar ditjesendatjes.nl/ winnen.
Ik ben ook maar een man is een openhartig boek over zelfleiderschap, kwetsbaarheid en vergeving, in een wereld die van mannen vooral verwacht dat ze sterk blijven. Erik Eerhart mixt persoonlijke verhalen met scherpe observaties en een vleugje humor. Hij laat zien dat kwetsbaarheid geen zwakte is, maar een kracht. Ook introduceert hij twee unieke ‘talen’ die mannen en vrouwen helpen zichzelf én elkaar beter te begrijpen. erikeerhart.eu

WINNEN!



WINNEN!
DenD verloot een Good4fun cadeaubon van 50 euro. Ga naar ditjesendatjes.nl/ winnen.





DenD verloot 3 gesigneerde exemplaren vaneenIkbenookmaar man. Ga naar ditjesendatjes.nl/ winnen.
Soms wil je geen geurkaars of sokken, maar gewoon keuze. Met een Good4fun cadeaubon zit je goed: te gebruiken voor dagjes weg, uit eten, fashion, make-up, games, elektronica, parfum of eten bestellen. good4fun.nl









































































































Vals herkent vals: Malgosia en Jaap.



Betrapt: tenen sabbelen.


















n n t g A
) , DE





Jaap viert de winst van De Gouden Kooi



is de absolute nummer 1 van dit moment. De Telegraaf-man treedt met zijn column op dinsdag in de voetsporen van wijlen Kees Lunshof. De overleden adjunct-hoofdredacteur bouwde een enorm gezag op met zijn dinsdagse column. Lunshof had tv-optredens niet nodig om bij opeenvolgende premiers op de koffie te gaan. De Winther kan het niet alleen goed uitleggen hoe de hazen lopen in Den Haag, hij weet ook tijdig te temperen terwijl anderen met hun analyses op hol slaan. Elke talkshow wil hem graag aan tafel hebben: van Eva tot en met de SBS-show Nieuws van de Dag. Ander pluspunt, Wouter toont ook enige zelfspot. Ook als hij niet aan het woord is en tussen het studiopubliek zit, kan hij met zijn grimassen impact maken.
Terror Jaap, echte naam Jaap Amesz, is tv-sabotage in mensvorm. HIj ontspoort zelden zonder opzet. Hij won De Gouden Kooi met manipulatie en effect, inclusief dat beruchte kotsmoment dat later nep bleek. In 2012, bij SterrenSpringen, riep hij al dat ze ‘een dikkerd voor de hilariteit' nodig hadden. Met 220 kilo en ‘mijn buik zit in de weg’ kondigde hij toch een salto aan, doodsbang maar te eigenwijs om af te haken. En nu zit hij gewoon in House of Villains. In aflevering 1 was het meteen prijs: „Goede ti*ten!” naar Małgosia, die terugkaatst met „kleine piemel!”. Daarna ging het hard: tongzoenen, teenzuigen in het bubbelbad, en een nacht die zij alsvolgt samenvat: ‘Wat daar is gebeurd, blijft tussen ons’. Jaap maakte het viezer met: „De keuzes die Małgosia vannacht maakte, waren in het voordeel van mijn handen.” Hij noemde het programma ‘heftig en bizar’, vol ‘verraad, haat en liefde’, en zei dat ze het later zelfs ‘met een psycholoog’ terugkeken. Małgosia sloot af met: „Maar Jaap krijgt nog een paar zweepslagen van mij, hoor…”



Reality-tv is het afvoerputje waar iedereen op neerkijkt en toch in blijft hangen. We doen alsof we het niet kijken, maar we weten precies wie met wie knalde, wie huilde en wie de boel sloopte. Dus: een Top 10 van de grootste reality-veelvraten. Niet de liefste BN’ers, wel de types met het dikste reality-cv, de hardste oneliners en het talent om elk VIPSformat naar zichzelf toe te trekken. Zet ze in een villa of jungle en je hebt binnen tien minuten gezeur.

Sylvia Geersen doet niet ‘af en toe tv’. Sylvia ís tv. Sinds Holland’s Next Top Model duikt ze op in alles waar je moet afzien, samenwerken of toneelspelen dat er geen camera’s zijn. Expeditie Robinson, Fort Boyard, De Verraders, Special Forces VIPS, De Alleskunner VIPS, De Bachelorette, Het Perfecte Plaatje, Stars on Stage, Het Jachtseizoen, Code van Coppens, Know Where to Hide, Het zwaard van Damocles, en dan hebben we Ranking the Stars, Sabotage, Shopping Queens VIPS, Jouw Vrouw Mijn Vrouw VIPS en Sterren Springen op Zaterdag nog niet eens gehad. De laatste tijd gaat het vooral over haar privéleven, niet over tv. Nadat ze ten huwelijk werd gevraagd, kwam haar verloofde Piet in opspraak, met geruchten over een strafblad en een arrestatie in Spanje op verdenking van drugshandel. En toen moest het Jeffrey Epstein-drama nog komen. Sylvia zegt dat ze hem voor haar ogen seksuele handelingen zag verrichten. „Ik heb nooit met iemand durven praten over wat er allemaal is gebeurd.”






























Sylvie met verloofde
Michella Kox verdedigt reality-tv op haar manier: met een gestrekt been erin. Toen Tooske Ragas in Shownieuws The House of Villains‘trash-tv’ noemden, stak Kox haar middelvinger op. „Wij worden niet aangestuurd, conflicten ontstaan vanzelf.” Zij is zelf het levende bewijs. Ze brak met Farja Farvardin nadat hij, zei ze, haar shirt omlaag trok en haar ‘in m’n blote ti*ten’ zette. Echte Meisjes in de






Jungle hoeft van haar niet meer: „Vorig jaar heb ik het gedaan en zat ik daar en dacht ik: Wat zit ik hier nu te doen met al die wijven?” Ze begon Dames in de Dop, ze won het, en sindsdien dook ze daarna op bij onder meer Shopping Queens VIPS tot House of Villains. Haar advies voor wie ook beroemd wil worden: „Lak hebben aan alles.”
Piet: „Geen strafblad.” ➜










met elk p
Hou


Tamara(links) als‘modemeisje’.

VIPS
Star
Tam
Ze w haa
en d
heef
quo





Samen met BFF
Tamara Elbaz is glamour met nul rem. Ze begon bij Modemeisjes met een missie en werd daarna vaste klant bij elk programma dat leeft van frictie: The Real Housewives of Amsterdam, Shopping Queens VIPS, First Dates VIPS, Ranking the Stars, Kom je bij me eten? VIPS en Tamara & Maria’s Therapy Trip. Ze werd landelijk gesprekstof door haar poep-in-de-hand-gewoonte en dat ze ooit een zwangere vrouw heeft aangereden. En dan zijn er de quotes waarmee ze de boel weer aanzwengelt. Over Sophie Hilbrand: „Ze ziet eruit alsof ze al twintig jaar geleden is gestorven en aan het ontbinden is.” Over modevrouw
aanz
jaar
Ma en d


Maria Tailor bij de rechtbank.




Marjan Strijbosch: „Een narcist pur sang.” Tamara kan keihard uithalen en daarna droog doen alsof het allemaal een misverstand was. Talpa had haar al binnen voor De Juice van Yvonne Coldeweijer, maar dat hangt nu boven de markt. Als ze slim zijn, leggen ze haar gewoon langer vast. Tamara stond vaker in de rechtbank dan haar lief was. Ze botste met Elvira Penthesilea over een Real Housewives-terrasruzie, waarbij €10.000 en het verwijderen van een post werd geëist, maar de rechter ging daar niet in mee. Tegelijk reageerde ze woedend op de taakstraffen voor de minderjarige verdachten die haar voor haar huis mishandelden, voor de ogen van haar zoontje. 4
Talp mishandelde,g






Louisa Janssen is al jaren een vaste naam in reality. Ze brak door met Louisa & Rowan en dook daarna op in alles waar je moet afzien of moet knallen: Echte Meisjes in de Jungle, Good Luck Guys en dat hele VIPS-rijtje. In Louisa&Rowan: Terug naar het Kamp zet ze zichzelf weer pontificaal in beeld. De jungle blijft haar ondertussen achtervolgen. Ze werd ooit uit het programma gezet na een vechtpartij, kreeg bij de reünie weer ruzie met Esmee en dropte die ene belediging die iedereen onthield: „Je bent net Sméagol uit Lord of the Rings.” Ze riep daarna dat ze klaar was met junglegedoe, maar zit nu toch weer in de familievariant, samen met haar moeder Hannie












































8

met het r bootfees dat ov va z en Hou haar Offici mense


Djamila Celina is in The Real Housewives of Amsterdam degene met het roze haar en de grootste mond. Op haar bootfeest ging het mis. Kimmylien beweerde Lilian intieme details had rondgestrooid over Roland Kahn, inmiddels de man van Cherry-Ann. Lilian ontkende, voelde zich klemgezet en wilde weg met: „Toedeledokie, b*tches.” Alleen, ze zaten op een boot. Djamila trok haar eigen grens: „Je moet nu even je bek houden. Als jij zo over mijn man had gepraat, had ik je overboord gepleurd.” En als er even geen tafel is om overheen te gaan, is er de ring. Bij Boxing Influencers stond ze tegenover Lena (Echte Meisjes in de Jungle) en later Amy de Winter (The Real Housewives of Antwerp). Daar is ze op haar plek, net als in House of Villains cieel een spel, maar vooral een reden om mensen af te branden.

Jaimie Vaes werd bekend via een relatie die ontspoorde terwijl de camera meeliep. Daarna volgde de breuk met Lil’ Kleine. Sindsdien bouwt ze aan een nieuwe versie van zichzelf, met reality als ruggengraat. In Jaimie: In The Vaes Lane verkocht ze herstel als therapie, co-ouderschap en designerjassen. Expeditie Robinson gaf haar in 2023 een onverwachte upgrade: ze haalde dag twintig en stapte uit omdat ze haar zoon miste. Daarna dook ze op bij SBS6 in Het waren 2 fantastische dagen met










Wesley Sneijder en balletdiva Igone de Jongh. In Het zwaard van Damocles stuurde ze de keuze richting de verkeerde kist, met ruzie en exit als resultaat. Haar eigen samenvatting was kort en raak: „Het was eten of gegeten worden.”











Famke Louise is de influencer-zangeres die ooit bij Jinek zei: „Ik heb superveel respect voor corona.” Sindsdien duikt ze op waar een camera, helm of junglehut staat. ExpeditieRobinson,HetJachtseizoen, The Masked Singer, De Verraders, EchteMeisjes indeJungle, SpecialForcesVIPS,
dit is haar natuurlijke omgeving. In de jungle ging het geen seconde over kokosnoten of zelfinzicht, maar over roddel, bondjes en wantrouwen, en Famke liet zich niks vertellen: „Jullie zijn schijnheilig”, „bek houden” en „ga niet in m’n gezicht praten”, het woord ‘slang’ lag er meteen bovenop. En toen SpecialForces VIPS, ongeveer het slechtste format voor haar, dus natuurlijk deed ze mee. Na één dag was het klaar: „Ik geef op. Ik ben ongeschikt. Dan kies ik voor mijn pizza op de bank.” Sinds 2024 verkoopt ze ‘exclusieve’ content achter een betaalmuur. In beeld blijven is bij haar geen hobby, het is het businessmodel.

Uitgeput bij Special Forces VIPS. ➜












































René Spoelstra noemt zichzelf op Instagram ‘lichaamstransformatie-expert’. Dat voel je meteen: strak in het shirt, strak in de regels. Ooit was hij de keurige vriend van Annebel Visscher in Temptation Island: Love or Leave. Hij kwam er opvallend heel uit, deed er zelfs een aanzoek achteraan en had even het imago van de zeldzame realityman die zich kan gedragen. Tot Power Couple, en daarna was het alsnog klaar. Sindsdien is hij vooral: de ex van Annebel.





In gelukkiger tijden met sexy Annebel.



In House of Villains pakt René al vroeg de troon en speelt hij de baas zonder te schreeuwen, wat het juist irritant maakt. Michella Kox had de ‘overheersende’ René na twee seconden door: „Zo zal een man nooit tegen me praten.”
nooit tegen me praten



Anke de Jong is geen klassieke BN’er. Ze komt uit de tijdschriftenhoek: eerst hoofdredacteur van Glamour, daarna ELLE. Later stapte ze uit de coulissen en het scherm op. Wie is de Mol? gaf haar in één klap een groot publiek, gevolgd door talkshowtafels en een podcast. Het Televizierring Gala deed de rest: het decolleté was zo diep dat het z’n eigen persbericht verdiende. Bij Vandaag Inside bromde Johan „Hallo!”, waarna er hardop werd gespeculeerd over een ‘ti*tenprijs’. In Pandora past ze daarom perfect: een BN’er-bondjesspel met een mythologisch sausje en vooral veel gekonkel. Anke speelt hard, wordt vervloekt, komt terug en zet Michiel Vos klem met één zin: „Je hebt me zo hard genaaid.” Ze snapt hoe het werkt: je hoeft niet de beste te zijn, als iedereen het er maandag nog over heeft, heb je gewonnen. ■









Ring-momentje: de stof won het niet.




















Noedels met tonijn, paksoi en ei


























Voor veel vrouwen is een handtas onmisbaar. Het nadeel van zo’n altijd-bij-je-tas is echter dat je er niet alleen essentials zoals een pen, telefoon en sleutels in bewaart, maar dat ook elk bonnetje, winkelwagenmuntje en kleingeld er zonder na te denken in verdwijnt. Waardoor die mooie handtas verandert in een onoverzichtelijke janboel waarin je niks meer kunt terugvinden. Door je tas op een vaste dag in de week op te ruimen en te reorganiseren, hou je 'm netjes en geordend.
ewaart, maar dat ook inkelwagenmuntje zonder na te denken Waardoor die mooie dert in een ke waarin je



Het is een beetje afhankelijk van het materiaal waar de tas van gemaakt is, maar de meeste tassen kunnen niet tegen direct zonlicht en warmte. Hierdoor kan het materiaal uitdrogen of verkleuren. Om je tas te beschermen tegen stof en licht, bewaar je hem als je ‘m niet gebruikt op een koele, droge plek, bijvoorbeeld in een stoffen zak of kussensloop. Hang de tas liever niet voor langere tijd op aan de handvatten of hengsels omdat de tas hierdoor kan vervormen.
Door je e in de week op hou oog je het tas , maar en gen en warmte. et rkleuren. Om rmen tegen waar hem bruikt roge eld ak ang et voor aan de erdoor .


























De getinte lippenbalsem van Caudalie verzorgt je lippen en geeft ze een mooie, langhoudende kleur. De superzachte balsam met karitéboter heeft een fruitige frambozengeur.






Handen wassen met water en zeep is onderweg niet altijd mogelijk, maar met een handgel in je tas heb je toch altijd schone handen. De frisse No-rinse Hand Gel van Marie-Stella-Maris reinigt én hydrateert.


… Schone handen ZONDER WATER … l van Ge gt aris reinig one den DER R
























Herkenbaar? Je gaat ‘s ochtends de deur uit met je haar los, maar in de loop van de dag gaan die losse lokken je toch irriteren. Met deze satijnen scrunchie
och unchie i je je haar snel in rt of knot.












Wie heeft er nog cashgeld op zak tegenwoordig? Het zijn vooral pasjes, dus een portemonnee is vaak niet nodig. In deze mooie wallet van Secrid passen tien pasjes en kun je ook biljetten kwijt.





… en dat zit het, want jij hebt deze handige compacte borstel-met-spiegeltje van de Hema in je tas. Openklappen, borstelen en direct het resultaat checken.



teren naar n van muziek…

Bellen, luisteren naar podcasts en genieten van muziek… goede oordopjes zijn onmisbaar. De Go Pop True Wireless Earbuds van JLab bieden urenlang draadloos luisterplezier. Ze zijn spatwaterproof en verkrijgbaar in diverse kleuren.








































In Spanje is Rosalía een absolute ster, haar populariteit raakt ook miljoenen fans ver daarbuiten. Rosalía Vila Tobella werd geboren op 25 september 1992 in Sant Esteve Sesrovires, een dorp nabij Barcelona met nog geen achtduizend inwoners. Ze groeide op in een Catalaans gezin, studeerde flamenco, hetgeen trouwens ongebruikelijk is buiten de provincie Andalusië en soms ook tot weerstand leidde.

ALa Perla is inmiddels een protestlied in Spanje dankzij een schoolklas die het nummer op YouTube plaatste.




op de vierkante centimeter met veel symboliek, zowel met een knipoog naar religie en Spaanse folklore.

nno 2026 galmt haar grote hit La Perla op alle radiostations, een authentiek meesterwerk volgens kenners. In elk geval één waarvoor de volumeknop wordt opengedraaid. Het is alsof Spanje dankzij Rosalía een nieuw muziekgenre heeft ontdekt. Ze schuwt niet om talloze muziekstijlen te combineren. Op haar laatste album nam ze in maar liefst dertien talen haar liedjes op.

Voor een nu al historische videoclip werd een compleet orkest in een huiskamer gepropt. Het resultaat is ongeëvenaard. Wie bedenkt zoiets? Ook de Verenigde Staten ontdekte Rosalía. Ze was recent nog te gast bij de talkshow van Jimmy Kimmel, waar ze met haar vingertoppen, het ritme van de flamenco nabootste, en samen met Kimmel La Perla zong. Jimmy Kimmel was onder de indruk van de jeugdige, sprankelende Spaanse furie.
In april staat Rosalía twee keer in de Amsterdamse Ziggo Dome, één van de vele haltes op haar wereldtour, die haar leidt van Europa naar andere werelddelen. Ze zal een verpletterende indruk maken. Haar leven bestaat uit muziek, muziek is haar leven, zo benadrukt ze. Toch was er nog ruimte voor de liefde, zoals met de Puerto Ricaanse zanger Rauw Alejandro. Die is vooral herkenbaar aan zijn bonte verzameling tattoos met op zijn borst een groot kruis.

Rosalía is een Spaans stijlicoon.
Rosalía is bovendien een stijlicoon op modegebied. Haar nagels zijn als stiletto’s. Het zijn mini-kunstwerken






Het sprookje tussen Rosalía en haar Rauw hield echter geen stand, maar was wel het groene licht voor de Spaanse zangeres om zich volledig te storten op haar muziek. De liefdespijn inspireerde haar om nog betere liedjes uit te brengen. „Eenzaamheid is de les van mijn leven”, zei Rosalía in een interview over haar gevoelsleven. „Ik ben een sociaal persoon. Ik omring mij het liefst door mijn vrienden, mijn familie. Ik geloof in de liefde.” ➜

Het nieuwe album van de Spaanse is weergaloos.












„Deze film is voorbij”, aldus hitzanger Rauw Alejandro over zijn relatie met Rosalía.





Het werd een avond vol spanning en sensatie in de Crypto.com Arena en het Peacock Theater in Los Angeles. De sterren van de avond waren Lady Gaga, Sabrina Carpenter, Bruno Mars en niet te vergeten Bad Bunny, die werd gelauwerd met de prijs voor het album van het jaar Debí Tirar Más Fotos.



DBad Bunny eindelijk ook eens zonder zonnebril.


e Nederlandse producer Roselilah, die bijdroeg aan het nummer ‘Luther’ van Kendrick Lalar & SZA viel op deze gala-avond eveneens in de prijzen. Maar er was nog meer kabaal. Veel gewaagd bloot op de rode loper met voorop model die zich voor de gelegenheid als een rolmops had verkleed. Bovendien werd presentator Noah, die de show voor de zesde en laatste keer presenteerde, door president Donald Trump bedreigd met een rechtszaak. Noah bracht Trump in verband met engerd Jeffrey Epstein. Verder werd de avond een lang protest tegen dezelfde Trump, maar het leverde wel mooie plaatjes op van veel vreemde en talentvolle kostgangers.

Billie Eilish, wanneer kom je weer naar Nederland?

d eveneens in de al. Veel odel Heidi Klum, had or Trevor laatste keer d bracht y n gers.





Heidi Klum moest naakt poseren voor de rolmopsjurk van ontwerpster Marina Hoermanseder.












Country-zangeres Shania Twain rockt met Stephen Sanchez (23!).







Nederlands succes voor Roselilah uit Utrecht.


























Verdine White stapte zo uit een stripboek met danseres Shelly Clark.


Kamie Crawford is verloofd en dolgelukkig...
ord .







Lady Gaga bedankt haar verloofde Michael Polansky.






Helemaal niets te verbergen hoor, vindt TikTokker Kennedy Eurich.

M th en d 2008
Zwee glitterg
‘ zeeme want de is er nog
Amster iederee kende




De Zweedse Zara Larsson maakt al jaren pophits, maar stond nu voor het eerst op de Grammy’s. Ze was genomineerd voor Best Dance Pop Recording met Midnight Sun. In de pre-show liet ze horen waarom ze daar thuishoort: geen grote show, wel een dijk van een stem… en dan die buikspieren! Op de rode loper ging Zara, die in 2008 op tienjarige leeftijd doorbrak door het winnen de Zweedse versie van GOT TALENT, vol in de zonmodus met glittergele couture van Kevin Germanier, met Swarovskijuwelen erbij. Ook haar haar werd een gespreksonderwerp: ‘zeemeermin’, los en golvend, en opvallend betaalbaar, want de hele OGX-routine kwam uit op 52,94 dollar. En dan is er nog dat Nederlandse meisje Julia Coster, de fan die in Amsterdam tijdens ‘Lush Life’ elke pas kende. Zara: „Nu moet iedereen die ik het podium op haal de dans kennen, want Julia kende de dans. Ze heeft de lat hoog gelegd, wat een koningin.”





Nederlands Julia ging viral na haar dansje bij een concert van Zara.








Zangeres
Madison Beer koos voor een ingetogen jurkje.

jaren mmy’s. Ze was ding waarom ze daar een stem… Zara, die in nnen de modus met warovskiderwerp: baar, r. En dan fan die in : „Nu moet n, want Julia en et um moment met r zag, dacht ik en . t zit je p g ,
„Ze spoot met spray” Julia over haarpodium moment met Zara: „Toen ik haar zag, dacht ik eerst: wow,wat ben je klein


Daarna: wow,wat zit je make-up perfect. Ze spoot met spray op mijn shirt, ik kreeg de microfoon en riep: Amsterdam, laat je likken!” ■






Deze Erin Lim Rhodes heeft het beredruk tijdens het rode-loper-seizoen.




Zara Larsson is het zonnetje in huis en dan moet de lente nog beginnen... Ze is al vijf jaar getrouwd met Joshua Rhodes. Ze hebben samen dochter Saylor.















Op de Kennedy’s na is er geen familie die dichter in de buurt komt van échte royalty dan de Beckhams. De Engelsen wisten al wie hij was voordat hij überhaupt geboren was: Brooklyn Beckham. Ik kwam achter zijn bestaan vanwege een interview met zijn vader David rond 2009. Die vertelde dat hij Brooklyn hielp met zijn huiswerk, maar dat hij het rekenen wel een beetje ingewikkeld vond. Destijds zocht ik toch even op in welke klas Brooklyn dan eigenlijk zat. Hij bleek tot mijn verrassing een jaar of tien te zijn. En dat David het toen al niet meer kon bijbenen, zegt net iets meer over hem dan hij wellicht zelf zou willen.
Fenomenale rechtervoet
Alzit er tenminste één positief aspect aan: de oud-voetballer heeft niet alleen een fenomenale rechtervoet, maar ook uitstekende mensenkennis. Want als je al de grootst mogelijke moeite hebt met huiswerk van de basisschool, dan is het maar goed als je er niet helemaal alleen voor staat in het leven. En gezien de lucratieve deals die hij heeft binnengesleept, heeft Beckham overduidelijk de juiste mensen om zich heen verzameld. Voor wie dat helaas niet lijkt te
gelden: hun inmiddels 27-jarige zoon Brooklyn. Op zijn zestiende was Brooklyn Burberry-fotograaf, op zijn 23ste trouwde hij zich in bij de steenrijke Amerikaanse familie Peltz, en nu is hij kok.
Het klinkt allemaal fantastischer dan het is, want zijn keuzes pakken vooralsnog rampzalig uit. Met name zijn kortstondige carrière als fotograaf was te pijnlijk voor woorden. Toen hij werd aangetrokken door modehuis Burberry - ik neem aan dat moeder Victoria een bloemetje heeft ontvangen voor het leggen van de contacten - dacht de wereld daarin een blijk te zien van uitzonderlijk talent. Ten onrechte, zo werd duidelijk toen de Beckham-telg een fotoboek publiceerde vol onscherpe, oninteressante kiekjes en de meest hilarische bijschriften. Zo lezen we: 'Olifanten in Kenia. Zo moeilijk om te fotograferen maar ongelooflijk om te zien.'
Beekse Bergen
M ocht u ooit in Safaripark Beekse Bergen zijn geweest, dan heeft u zeer waarschijnlijk een interessantere olifantenfoto gemaakt dan Brooklyn Beckham. Die stopte uiteindelijk met zijn fotografie-

Het glamourgezin van David en Victoria Beckham valt uiteen. Zoon Brooklyn (hier met echtgenote Nicola Peltz) beklaagt zich over gebrek aan kansen.




opleiding in New York omdat hij naar eigen zeggen, en hier wordt het ironisch, ‘heimwee’ had naar zijn familie in Engeland. Diezelfde familie die hij onlangs grandioos te kakken zette op Instagram.
Nu Brooklyn een nieuwe familie heeft, vindt hij zijn oude ineens vreselijk. Volgens Brooklyn draait het bij de Beckhams allemaal om geld en reputatie en was zijn eigen wel en wee daaraan ondergeschikt. Dit klaarblijkelijk in tegenstelling tot de steenrijke familie van zijn nieuwbakken vrouw, die onder meer gul doneert aan de veroordeelde viezerik Donald Trump in ruil voor politieke invloed. Als het niet zo treurig was, zou je er bijna om lachen. Want Brooklyn lijkt de concepten ‘privilege’ en ‘trauma’ een beetje door elkaar te halen. Hij dankt werkelijk alles in zijn leven aan het feit dat zijn ouders bekend zijn, maar beklaagt zich vervolgens over de kleur van het dienblad waarop al die kansen worden aangeboden.
O nderwijl lachen de Britse tabloids zich een kriek. Ze hebben zelfs het oude kindermeisje
van de Beckhams, onze ‘eigen’ Rebecca Loos, uit de mottenballen getrokken om de schandalen te becommentariëren. Loos had ooit naar eigen zeggen een affaire met David, en vindt de aandacht van de pers duidelijk nog fijner dan de seks met de oud-voetballer. Brooklyn, de arme drommel, lijkt niet te begrijpen dat hij alleen maar méér olie op het vuur gooit.
Zijn tatoeage met ‘dad’ (‘papa’) heeft hij inmiddels laten weglaseren, de hele familie is geblokkeerd op instagram en zijn kookkunsten knappen er ook niet van op. Nu blonk hij ook daar sowieso nooit in uit, maar zijn kijkers maakten zich toch een beetje extra zorgen toen hij een spaghetti bolognese opdiende zonder spaghetti of knoflook. Koning WillemAlexander moet toch wel heel blij zijn dat hij drie tamelijk verstandige dochters heeft. En dat we in Nederland niet zo’n meedogenloze tabloidcultuur hebben als de Britten. ■





























Aviko Pom’ Duchesse zijn gemaakt van licht gekruide puree en voorzien van een krokant jasje. Met deze heerlijke aardappeltoefjes maak je elke maaltijd heel eenvoudig leuker en lekkerder. Ze zijn snel te bereiden in de oven, friteuse of airfryer. Kijk voor receptinspiratie op aviko.nl A�ko. El� dag













EMILE BODE
Klustips & tricks




In juni schrijf ik 25 jaar over het huishouden. In die tijd voltrok zich een stille revolutie waar relatief weinig over is geschreven. In dit tijdsbestek namen steeds meer mannen zorgtaken op zich en dat is volgens mij volstrekt logisch.
Vrijwel alle (jonge) vrouwen werken buitenshuis. Dat moet trouwens ook om financiële redenen, want anders kun je bijvoorbeeld nooit een huis kopen. Nog interessanter is het feit dat steeds meer dames een beter betaalde en hoge functie bekleden. Wat dat betreft is het een en al girl power. Veel lezeressen van dit maandblad
kennen nog de tijd dat de man de kostwinner was en de dames zich over het huishouden ontfermden.
Jonge pensionado’s Het zal geen verbazing wekken dat vooral oudere mannen er moeite mee hebben hun plaats in het huishouden te vinden. Ook als zij gepensioneerd zijn. Het zijn met name de tachtigplus dames
die het vaak door de vingers zien dat hun man niets wil, of kan. Bij de jonge pensionado’s is dit beeld anders. Ook opa Emile is niet te beroerd om de poepluier van het kleinkind te verschonen. Ik krijg met enige regelmaat mails van dames die klagen dat hun gepensioneerde man geen bal in het huishouden uitvoert. Lieve dames, als uw
echtgenoot een klusje doet, moet u uw waardering uitspreken. Waardering is de beste manier om uw echtgenoot aan het werk te krijgen. En ik ken menige man die, als weduwnaar, opeens wel alles kan.
In ons huishouden zwaait mijn vrouw de scepter. Ze doet de hele was, kookt het meest, regelt de boodschappen en stoft zich een ongeluk. Zelf doe ik de zware klussen, maar ook de vloer dweilen, ramen wassen, kleine defecten repareren en het onderhoud van de tuin, inclusief

de schuren. Als ik op een bepaald moment geen betaald werk meer verricht, vrees ik dat ik meer moet doen. Of vaker met vakantie.
De meest favoriete taken van mannen zijn stofzuigen en de vaatwasser in- en uitpakken. Een minderheid kookt graag. Overigens is onderzocht dat een relatie gelukkiger is als partners de huishoudelijke taken in evenredigheid verrichten. Een van mijn schoonzonen pakt de wasmachine met militaire precisie in en zet alles keurig op rij. De stoelen staan op de millimeter nauwkeurig onder de tafel. Mijn dochter wordt daar soms gek van. Zo ziet u maar, de man wordt meer ‘vrouw’ en de vrouw meer ‘man’.









Wanneer zijn de winkels op zondag geopend?
Het valt in ons land niet altijd mee om te weten wanneer er een koopzondag is. Zelfs niet in uw eigen gemeente.
In de grote steden zijn de meeste winkels op zondag meestal open, tenzij de eigenaren daar geen zin in hebben. Elke gemeente hanteert zijn eigen openingstijden. Supermarkten zijn doorgaans het eerst open, en sluiten het laatst. Als u het niet zeker weet, kunt u het beste tussen 13 en 17 uur winkelen.In tal van andere gemeenten zijn de winkels meestal op de eerste zondag van de maand geopend.
Maar bijvoorbeeld in Tiel is dan misschien slechts de helft van de winkels open, wat niet bevorderlijk is voor de gezelligheid van het straatbeeld. In ons favoriete winkelcentrum zijn op koopzondag alleen de twee supermarkten en een
drogisterij open. De eigenaar van de slijterij zegt daarover: „Als ik open ga, verdien ik bijna niets en ik gun mezelf ook een vrije dag.” In steeds minder gemeenten zijn alle winkels nog op zondag gesloten. Dat geldt vooral voor gemeenten waar de orthodox-christelijke kerk een sterke aanhang heeft, ook in de gemeenteraad. Denk aan Urk, Raalte, Staphorst en Opheusden. De horeca is wel gewoon open.
In het christelijke Veenendaal zijn veel winkels sinds enkele jaren wel op zondag geopend. De christelijke partijen in de gemeenteraad delfden daar tijdens een stemming het onderspit. In België zijn de winkels meestal ook maar één keer per maand geopend, van 10.00 tot 18.00 uur. Dat geldt ook voor Duitsland.
Kijk op openingstijden.nl













































ezeres ui







Een lezeres uit Renkum bezit een oud polshorloge van haar overleden man. Het horloge van een wereldberoemd merk is defect. Het glas is gescheurd en het pinnetje ontbreekt. Zij wil het laten repareren om het aan haar enige zoon te schenken. Zij vroeg mij waar zij met dit horloge naar toe kan? Het beste startpunt is de website uurwerkherstellers.nl. De aangesloten horlogemakers met het logo UF wisselen onderdelen uit met circa driehonderd andere uurwerkherstellers. Dat is van groot belang bij (de reparatie van) oude uurwerken.




















Een schort is een onmisbaar attribuut in de keuken. Je hebt ze in alle soorten en maten. Wat ik belangrijk vind, is dat een schort een insteekvak heeft. Er bestaan veel soorten schorten. Een klein schort van een serveerster wordt een evaatje genoemd. Die zie je steeds minder. Een lang schort in de horeca is veel populairder, ook bij dames. Zo’n schort van heup tot voeten heet een sloof. Een groot werkschort, zoals bij slagers, heet een voorschoot. Zitten er twee zakken in, dan spreken we van een schoenmakerssloof.


























Een tijdje geleden werd bij mij een achterste kies getrokken. Het duurde zeker twee weken voordat de nare lucht uit mijn mond verdween. Ik vroeg de tandarts of mondwater helpt. Wat blijkt? Als je het enkele weken gebruikt, is er niets aan de hand, maar bij dagelijkse aanvulling op de gewone mondverzorging kan dat leiden tot verkleuring van de tong en de tanden.Het belangrijkste is goed poetsen, flossen, de tong schrapen en voldoende water drinken. Mondwater doodt wel slechte bacteriën in de mond, maar ook de goede. Mondwater met alcohol wordt afgeraden, omdat dit de speekselproductie vermindert. Mondwater zonder alcohol is niet verkeerd. Op de website van tandartsnijmegenoost.nl wordt het redelijk nieuwe merk CB12 aangeprezen. Ook mijn mondhygiëniste noemde dit merk. Het is wel duur, maar u kent mij. CB12 bevat fluoride, zink en chloorhexidine. Op de site vraagdetandarts.nl wordt het merk Oxy Fresh Lemon Mint mondwater het best beoordeeld, maar niemand in mijn omgeving kent dit merk. Het is prijzig, maar als het helpt wanneer u uw minnaar intens zoent, dan is dit elke euro waard.

ood van tgenoot e een de garage am daar nreiniger De auto middels daan. gebruikt ddel om tten te sen.
Na de dood van haar echtgenoot ruimde een mevrouw de garage op en kwam daar autovelgenreiniger tegen. De auto was inmiddels weggedaan. Sindsdien gebruikt zij het middel om de gaspitten te poetsen.




















































Maart is zo’n maand die nergens echt bij hoort. De winter hangt nog wat rond, maar in de tuin zijn de eerste tekenen van de lente al duidelijk zichtbaar. Blauwe druifjes steken hun kop op, laag bij de grond, met felle blauwe trosjes. Ze zijn er vroeg bij, vaak al in maart, en blijven meestal nog even staan. Soms ruik je ze licht zoet; ze trekken meteen de eerste bijen aan. Alsof ze het startsein geven voor de rest. Daarna komt het langzaam op gang. Fruitbomen kunnen nog worden gesnoeid voordat ze uitlopen. Borders mogen worden opgeschoond en krijgen een laag compost. Binnen kun je blijven zaaien en ook buiten kan voorzichtig wat de grond in, zoals sla, spinazie of radijs, zolang het tenminste niet meer vriest. Vogels vinden steeds meer zelf hun eten, maar water en beschutting blijven nodig. Mulch gebruik je nu vooral om de bodem rustig te houden.

De tuin ligt er nog rommelig bij, maar dat is geen reden om te wachten. Dit is het moment om op te ruimen en ruimte te maken. Terrassen kunnen worden schoongemaakt, potten leeggehaald of opnieuw gevuld en tuinmeubels gecontroleerd. Wat de afgelopen maanden is blijven liggen, kan weg. Lichtsnoeren mogen blijven hangen, maar verder draait het om overzicht en gebruiksgemak. Kijk waar straks wordt gelopen en gezeten en richt daar de tuin op in. Groenblijvers en siergrassen zorgen voor structuur, vroege

1 SNOEIEN


Snoei zolang knoppen nog niet vol openstaan.







bloeiers brengen de eerste kleur. Wie dit nu aanpakt, zit straks niet te rommelen als het weer meewerkt.Vogelhuisjes en takkenhopen laat je natuurlijk met rust, daar wordt nu gebouwd en geschuild.


Geef de bodem aandacht met compost of goed verteerde mest.






Zaai sla, spinazie, radijsjes of tuinkers buiten of op de vensterbank. 3



















De tuin oogt nog rustig, maar dit is een geschikt moment om bessenstruiken te planten, zolang de grond niet bevroren is. De planten staan stil en kunnen zich goed zetten voordat de groei begint. Dat geeft ze een voorsprong voor het seizoen dat volgt.
Bessenstruiken zijn voedzaam en smakelijk, maar brengen ook leven, structuur en biodiversiteit in de tuin. Er zijn diverse soorten, elk met hun eigen manier van groeien en verzorgen. Frambozen zijn geliefd om hun sappige, zoete vruchten en snelle groei. Ze bloeien op éénjarige scheuten en hebben vaak ondersteuning nodig, bijvoorbeeld een rek of draad.


vogels aan. Blauwe bessen vragen meer aandacht. Ze groeien het best in zure grond en op een zonnige plek en leveren bessen die rijk zijn aan voedingsstoffen. Planten in deze fase heeft voordelen. De struiken zijn nog niet actief aan het groeien en hebben daardoor minder last van verplanten. De bodem is meestal goed te bewerken, waardoor wortels zich gemakkelijker kunnen verspreiden.
Bessenstruiken zijn praktisch en decoratief. Wie nu plant en snoeit, plukt straks de vruchten.
bijhouden maakt het verschil tussen een rommelige struik en een productieve plant.
Pluk de vruchten
Bessenstruiken zijn praktisch en decoratief tegelijk. Ze bloeien, trekken insecten aan en geven de tuin vorm. Met aandacht bij het planten en onderhoud leg je de basis voor een sterke groei en een goede oogst van gezonde, heerlijke bessen in de zomer. Wie nu plant en snoeit, plukt straks de vruchten van een slimme start. ■
Kruisbessen en aalbessen zijn sterk, doen het goed in vruchtbare, goed doorlatende grond en geven jarenlang opbrengst. Ze komen voor in rood, wit en zwart en trekken
Werk compost door de grond, maak ruim plantgaten en houd voldoende afstand tussen de struiken. Een laag mulch rond de basis helpt om vocht vast te houden en de wortels te beschermen tegen temperatuurschommelingen. Snoeien hoort bij het verzorgen van bessenstruiken. Het zorgt voor lucht en licht en houdt de plant gezond. Bij frambozen worden de oude scheuten verwijderd, zodat nieuwe ruimte krijgen. Kruis- en aalbessen vragen om uitdunnen om schimmel en ziektes te voorkomen. Regelmatig
Bessenstruiken zijn langetermijndenkers. Het eerste jaar doen ze het vaak nog rustig aan, daarna komen ze steeds beter op gang. Met een beetje snoei en aandacht blijven ze jarenlang fruit geven. Je plant ze één keer en plukt er elke zomer opnieuw van.
omer r opnieuw w v van.


























We hebben een héél lekker nieuwtje, Almhof yoghurtmousse! Een heerlijke zachte mousse met de frisheid van yoghurt. Gemaakt met de beste ingrediënten, verkrijgbaar in de smaken perzik maracuja en aardbei.
Een ultiem verwenmoment voor jezelf, want zo lekker kan luchtig zijn.
alle lof voor Almhof”

















































Kijk dan op




Twee losse ideeën voor een lekkere avondmaaltijd. Zin in pasta? Ga voor penne met zalm en groene asperges in romige knoflooksaus. Snel op tafel en net even luxer dan je doordeweeks verwacht. Liever iets dat je zo uit de hand eet? Maak kip-taco’s met avocado en een frisse yoghurtsaus. Je vult ze zoals jij het lekker vindt.

✔ 3 tenen knoflook




✔ 500 g penne
✔ 300 g verse zalm
✔ 200 ml kookroom
✔ 500 g groene asperges
✔ 1 rode ui
✔ 1 visbouillonblokje
✔ 15 g verse peterselie
✔ Olijfolie
✔ Peper en eventueel zout

✔ 12 tacoschelpen
✔ 400 g kipfilet

Bereiding voor vier personen
• Kook de penne in ruim gezouten water volgens de aanwijzingen op de verpakking. Giet af en bewaar een kopje kookwater.
• Snijd de rode ui fijn, hak de knoflook en peterselie. Snijd de zalm in blokjes. Snijd het houtige stukje van de asperges weg en snijd de rest in stukjes van ongeveer 3 cm.
• Verhit olijfolie in een grote pan en bak de asperges 4–5 minuten tot ze beetgaar zijn. Haal ze uit de pan en zet apart.
• Verhit in dezelfde pan opnieuw wat olie, fruit de rode ui glazig en bak de knoflook kort mee.
• Verkruimel het visbouillonblokje boven de pan en voeg de kookroom toe. Laat 2–3 minuten zacht pruttelen.
• Voeg de zalm toe en laat 3–4 minuten zachtjes garen, roer voorzichtig. Doe de asperges en penne erbij en meng rustig door. Voeg eventueel wat kookwater toe als de saus te dik is.
• Breng op smaak met peper en eventueel zout. Strooi vlak voor serveren de peterselie erover.

✔ 1 rode ui
✔ Olijfolie

✔ Kipkruiden naar smaak
✔ 1 kleine krop ijsbergsla, fijngesneden
✔ 1 blikje maïs
✔ 2 avocado’s
Voor de saus
✔ 200 g Griekse yoghurt
✔ 1 teen knoflook
✔ Peper en zout


Bereiding voor vier personen (12 taco’s)
• Pers de knoflook en meng deze door de Griekse yoghurt. Breng op smaak met peper en zout. Zet even in de koelkast zodat de smaken intrekken.
• Snijd de kipfilet in kleine blokjes of reepjes en meng deze met de kipkruiden.
• Snijd de rode ui in dunne ringen. Snijd de avocado’s doormidden, verwijder de pit en snijd het vruchtvlees in blokjes. Doe dit het liefst vlak voor het vullen, dan blijft het mooier. Snijd de ijsbergsla fijn.
Meng de pasta niet op je bord, maar in de pan. Giet de penne af, doe hem terug bij de saus en zet het vuur laag. Schep een halve minuut rustig om. Dan neemt de pasta de saus beter op en blijft die niet als een laagje eromheen hangen. Is de saus te dik? Voeg dan een klein scheutje kookwater toe. Dat water zit vol zetmeel en dat bindt, waardoor de saus gladder wordt en beter aan de pasta kleeft.

• Verhit wat olijfolie in een koekenpan en bak de gekruide kip in 6–8 minuten goudbruin en gaar.
• Verwarm de tacoschelpen volgens de aanwijzingen op de verpakking, meestal kort in de oven. Vul elke taco met eerst wat ijsbergsla, daarna de kip, maïs, avocado en rode ui.
• Lepel er als laatste het yoghurtsausje overheen.


Altijd lekker, zo’n Bolletje cracker!






















Veel mensen vragen mij wat een populaire witte wijn is. Dat waren lang de chardonnay en sauvignon blanc, maar tijden veranderen. Sauvignon blanc is ingehaald door pinot grigio. Intussen zie je een nieuwe trend opkomen, en dat is de verdejo-druif.
Een witte druif die bekendstaat om frisheid en aroma’s, denk aan citrus, groene appel en verse kruiden. Verdejo is meestal droog, lekker doordrinkbaar en bedoeld om jong te drinken. Dat maakt hem zo populair als borrelwijn, vooral bij warm weer. De beste verdejo komt uit Rueda, in Castilla y León, ten noordwesten van Madrid. De arme, stenige grond zorgt daar voor frisheid en concentratie. DO Rueda is het officiële keurmerk, dus let daar op bij aankoop. Voor liefhebbers is er ook verdejo met houtrijping.



De Amaretto Sour is zoet met een zure tik, dankzij amaretto en citroen. Hij drinkt makkelijk weg, maar heeft genoeg pit om niet saai te zijn. Pas op, want voor je het weet is je glas leeg.
1
Vul een shaker met ijsblokjes.

2
Giet 90 ml Finest Call Sweet & Sour mix in de shaker.
3

Shake stevig tot de shaker ijskoud aanvoelt.

Voeg 45 ml Disaronno Amaretto toe.

4



5 Schenk uit in een tumblerglas en garneer met een schijfje gedroogde citroen.



Sappig en aanhoudend fris kun je deze verdejo uit Rueda wel noemen. Tel daar tonen van exotisch fruit bij op en je hebt een top verdejo. ief.
Een wijn met mineralen, tropisch fruit en kruidig (munt), en dat allemaal in één glas. En dan ook nog een beetje licht gerookt. Dan heb je echt een top verdejo te pakken en komt de inheemse druif volledig tot zijn recht.
LEKKER BIJ: Gerookte vis, gevogelte en kalfsvlees.



LEKKER BIJ: Frisse salade of als aperitief.






Zó blijft je verdejo lekker fris!
Het juiste glas maakt verschil. Verdejo wil je fris en strak houden, dus pak liever een kleiner wijnglas en schenk het niet tot de rand vol. Zo blijft je wijn langer koel en proef je die citrus en kruidigheid veel beter. In een groot, bol glas warmt de wijn snel op en wordt die eerder vlak, alsof je die al te lang hebt laten staan.




Eén keer per week loopt Amaris van der Plas bij Dirk binnen voor haar weekboodschappen. Geen omwegen of luxe franje, maar kopen wat nodig is voor een prijs die klopt: „Daar houd ik van.”
In haar mandje zit altijd karnemelk. „Ik drink elke dag een glas”, vertelt Amaris van der Plas. „Vroeger vond ik het echt niet te drinken, maar nu kan ik niet meer zonder.” Verder pakt ze bij Dirk meestal hetzelfde voor ontbijt: havermout en bevroren fruit. „Dat is mijn basisontbijt. Simpel, voedzaam en betaalbaar.” Amaris voelt zich thuis bij de ‘Principes van Dirk’. Dezelfde lage prijs voor iedereen, bijvoorbeeld.
„Ik vind het een prettig idee dat niemand meer betaalt dan een ander. Het is eerlijk.”
Zelf halen is geld besparen
Ook het idee dat je bij Dirk alles kunt kopen wat je nodig hebt voor een Dirk-prijs spreekt haar erg aan. „Ik hoef niet naar drie verschillende winkels. Ik kan hier mijn hele week regelen.”
Wat haar verder aanspreekt, is de mix van grote merken en kleine prijzen. „Ik koop graag bekende producten, maar dan wel betaalbaar.” En ja, zelf halen is geld besparen: ook dat principe past bij haar. „Je pakt je spullen zelf, het is overzichtelijk, geen poespas. Dat houdt het laagdrempelig.”
Amaris’ favoriete plek is de zuivelkoeling. „Dat klinkt misschien een beetje raar, maar ik krijg daar echt een nostalgisch gevoel van.”
De koelafdeling herinnert haar aan vroeger, aan boodschappen doen met haar ouders. „Die koude, dat felle licht, het voelt vertrouwd.”
Betrouwbaarheid
Voor Amaris is Dirk vooral een supermarkt zonder poespas. Geen schreeuwerige aanbiedingen of onnodige luxe, maar een overzichtelijke winkel waar je snel vindt wat je zoekt. „Ik kom hier voor betrouwbaarheid”, zegt ze. „En ik ga altijd met alles naar huis met wat ik nodig heb.” Eenmaal thuis begint het dan weer als vanouds met: havermout, fruit en een glas karnemelk... ■









DenD






De Liffey Bridge ook wel Ha’penny Bridge genoemd, vanwege de tolheffi
g

















Smmalle straatjes, lli b d
gezellige pubs en de geur van versgebakken lekkernijen maken Dublin onweerstaanbaar. Hier is Guinness niet zomaar een bier, maar traditie. Wie in de Ierse hoofdstad rondwandelt, voelt zich meteen thuis.























































Guinness is onlosmakelijk verbonden met Dublin.














Een typisch Iers ontbijtje.

















reske straatjes en het cultuur- en winkelaanbod is ronduit geweldig.
Maar Dublin is vooral de stad van pubs, talloze eethuisjes en een zeer gemoedelijke bevolking. Zo waarschuwde onze praatgrage taxichauffeur direct dat je altijd moet toekijken als jouw Guinness wordt ingeschonken. Dit om te beletten dat een halfvol glas dat er misschien nog staat, wordt aangevuld. Of dat ook echt gebeurt? Geen idee. Ook weten we niet of er iets klopt van de haast magische krachten die locals toekennen aan dit typisch Ierse bier. „Wij bestellen aan de bar overigens geen Guinness, maar Stout”, leerde de taxichauffeur ons.



De National Gallery of Ireland is gratis te bezoeken en een absolute aanrader. Wat een geweldige kunstcollectie!








Voor wie het drankje niet kent: Guinness is een donker Iers biermerk dat zijn oorsprong


Saint CathedralPatrick’s is de grootste kerk van Ierland.
in Dublin heeft. De Guinness Brouwerij, de St. James’s Gate Brewery, is onlosmakelijk met de stad verbonden, zoals Philips en Eindhoven dat vroeger waren. Het bier smaakt fluweelzacht en is een
Dublin is veel meer dan een glas Guinness
symbool van de Ierse cultuur. Maar Dublin is veel meer dan Guinness. Het is ook de stad van de kleurrijke bruggen over de Liffey. Deze rivier mondt uit in de Baai van Dublin en splitst de stad in tweeën.
Dan maar zwemmend
Onze taxichauffeur wees ons de iconische Liffey Bridge. Deze gietijzeren brug wordt ook wel de Ha’penny Bridge genoemd, omdat mensen die wilden oversteken vroeger een halve penny moesten betalen. „Wie zich dat niet kon
permitteren, moest het elders proberen of naar de overkant zwemmen”, zegt de chauffeur lachend. Zoals gezegd zijn er inmiddels vele bruggen; de brede O’Connell Bridge verbindt de gelijknamige straat met de zuidkant van de stad; de opvallende Samuel Beckett Bridge in de vorm van een harp; de James Joyce Bridge (in de vorm van een opengevouwen boek, als eerbetoon aan de Ierse schrijver James Joyce) en de prachtige Seán O’Casey Bridge. Stuk voor stuk zijn ze fantastisch verlicht.
Om een goede indruk van de stad te krijgen, is de hop-on-hop-off bus echt een aanrader. Het bracht ons onder andere bij het Irish Museum of Modern Art (IMMA) in het Royal Hospital Kilmainham. Het zeventiende-eeuwse pand was ooit een tehuis voor gepensioneerde soldaten, maar herbergt nu een hedendaagse kunstcollectie. Het museum is gratis te bezoeken. Ook de naastgelegen IMMA Gardens zijn een aanrader. De structuur van de zeventiende-eeuwse lanen, zichtlijnen en binnenplaatsen is grotendeels intact gebleven.
16.000 kunstwerken
We kregen de smaak te pakken en besloten ook de National Gallery of Ireland te bezoeken. Dit eveneens















































Scan voor meer receptinspiratie
www.mekkafood.com/nl/inspiratie















































gratis toegankelijke museum, waarvan het oudste deel dateert uit 1864, heeft werkelijk een fantastische collectie van meer dan 16.000 kunstwerken. Schilderijen van kunstenaars als Rembrandt, Vermeer, Titiaan, Degas, Caravaggio en Monet. Ook zijn er regelmatig exposities waarvoor de bezoeker wel een kleine bijdrage moet betalen.

























Op zoek naar dat ene Ierlandwhiskey-merk? heeft het.

Een theaterbezoek stond eveneens op de agenda. Veel voorstellingen bleken volledig uitverkocht, maar het Bord Gáis Energy Theatre had nog kaarten voor de musical Moulin Rouge. We besloten ons in de Ierse hoofdstad onder te dompelen in het verhaal van deze Parijse nachtclub. De show was indrukwekkend, maar dat is het gebouw ook. Het is een architectonisch hoogstandje van de wereldberoemde architect Daniel Libeskind. Van buiten zeer modern, maar eenmaal binnen ouderwets ‘rode-fauteils-gezellig’.
Irish stew
Het cultuuraanbod is groot, maar Dublin is vooral de stad waar je heerlijk kunt ronddwalen. Het is één en al gezelligheid, niet in de laatste plaats dankzij de optredens van de vele straatmuzikanten.
‘Shop till you drop’ doe je in Grafton Street, Henry Street, O’Connell Street en Talbot Street. Als je er




Dublin is vooral de stad waar je heerlijk kunt ronddwalen

belangstelling was tijdens ons weekendbezoek groot.
Smaakt naar meer

bijna bij neervalt, is er altijd een pub binnen handbereik. En niet alleen voor een glas Guinness! Ook gerechten als Irish stew (voorzien van Guinness) en fish and chips zijn vrijwel overal verkrijgbaar. Vaak blijft het niet bij eten en drinken: in een aantal pubs is ook traditionele Ierse muziek live te horen. Het vergt wel enige lenigheid om jezelf naar binnen te worstelen, want de










Een lang weekend in Dublin smaakt net als een goed glas Guinness naar méér. De Ierse hoofdstad is zeker geen metropool, maar juist die knusheid maakt Dublin zo bijzonder. Dat geldt ook voor de vriendelijkheid van de locals! Het is vanaf Schiphol anderhalf uur vliegen naar Dublin Airport. Daarna heeft de taxichauffeur een halfuurtje nodig om je naar het centrum van de stad te rijden, vanwaar je de meeste bestemmingen gewoon te voet kunt bereiken. Wij keren spoedig terug! ■

Trinity College, de oudste universiteit van het land.






































SPANJE
Casa Nassau is niet het eerste buitenlandproject voor Geert en Helen. Deze bereisde familie woonde vanwege het werk van Geert in de afgelopen 25 jaar al in zeven verschillende landen. „Het was altijd al onze droom om gedeeltelijk in het buitenland te wonen. Het leven voelt vrijer.”
Geert en Helen hebben bewust voor de regio tussen Valencia en Alicante gekozen vanwege de gezellige mensen, de rijke cultuur en de ligging in een microklimaat waar het weer zowel in de zomer als in de winter goed is.
Geert vertelt: „Het is heel veelzijdig hier. Buiten de stranden en de typische zomervakantie is er nog zoveel meer te doen. Het is een bergachtig kustgebied met prachtige routes om te rijden, fietsen of hiken. Valencia ligt op een uurtje rijden voor een leuke citytrip.”
Vincent: „Een schitterend nieuw gerenoveerd huis. Met veel aandacht en liefde ingericht. Wij hebben hier met zes volwassenen en een kleintje een lekkere tijd gehad.”
Ook zijn er binnen een straal van vijftien kilometer pittoreske dorpjes zoals Altea, Guadalest en Jávea. Het huis heeft een adembenemend uitzicht op het heuvellandschap en de zee. In 2024 is de villa grondig gerenoveerd, zeer sfeervol ingericht en van alle gemakken voorzien. Het huis heeft vijf slaapkamers, vier badkamers en is geschikt voor maar liefst tien personen. Ideaal om met twee gezinnen op vakantie te gaan, want er is ook een appartement op de begane grond met een eigen woongedeelte en keuken.
De fraaie tuin is zeer ruim met een groot zwembad, zithoeken onder pergola’s, ligbedden en zitzakken. Het huis heeft ook een prachtige rooftop met 360 graden uitzicht over de hele regio. Helen laat enthousiast weten: „Het voelt heel goed voor ons om ook anderen van het huis te laten genieten. En via Micazu hebben we eigenlijk alleen maar fijne mensen over de vloer gehad.” ■

Benissa (Costa Blanca)

GESCHIKT VOOR 1-10 personen
BOEKEN Geen boekingskosten en direct contact met Geert & Helen.
BEOORDELING 9,6
MEER INFO? Scan de QR-code

OOK JOUW VAKANTIEHUIS VERHUREN? Begin met verhuren en ontwerp vrijblijvend je advertentie op Micazu.nl


De lente hangt in de lucht! En dat betekent dat de tulpenparken weer heerlijk in bloei staan. Bezoek naast de Keukenhof ook eens Tulip Experience.

Fiesta Gitana Morèl toert van 1 t/m 19 april door het land. Deze hommage aan de flamenco puro, de ware flamenco, is een zinderend muzikaal spektakel. Verwacht een energieke mix van flamencodans, explosieve zapateados (voetenwerk), hartstochtelijke zang en virtuoos gitaarspel, opgezweept door vurige palmas (handclaps). vaarzonmorel.com

Aladdin is terug! Cinema in Concert, in samenwerking met het legendarische Residentie Orkest, presenteert: Disney’s Aladdin in Concert Live to Film. Je kijkt de film uit 1992 in Rotterdam Ahoy en het orkest speelt de hele soundtrack live. Voor wie ermee is opgegroeid én voor wie het voor het eerst ontdekt. Te beleven op 10 en 11 april. cinemainconcert.nl

Een warme, muzikale avond vol humor, ontroering, prachtige verhalen én onvergetelijke muziek. Cor Bakker en Maarten Heijmans toeren in maart, april en mei door het land met ‘Ramses enzo...’. Pianist Cor Bakker begeleidde Shaffy meermaals tijdens zijn optredens. Acteur en zanger Maarten Heijmans kroop later met groot succes in de huid van Ramses in de bekroonde televisieserie ‘Ramses’, waarmee hij de iconische zanger opnieuw tot leven bracht. corbakker.nl/ramses
Tulip Experience Amsterdam is een must-visit tijdens een bezoek aan de Bollenstreek. Met een tulpen museum, een showtuin met maar liefst 4 miljoen tulpen (in zevenhonderd soorten!) en het plukken van tulpen in de indoorplukkerij (inbegrepen in het ticket!) dompel je je onder in de wereld van de tulp. Het familiebedrijf achter de Tulip Experience kweekt al drie generaties met veel passie tulpen. Geopend van 19 maart tot 10 mei in Noordwijkerhout. tulipexperienceamsterdam.com



Zodra de Keukenhof in Lisse op 19 maart haar deuren weer opent, zie je direct waarom het park wereldwijd zo bekend is. Miljoenen tulpen, hyacinten en narcissen staan in bloei, aangevuld met nieuwe bloemenshows en thematuinen. Voor de ultieme lentedag! Geopend van 19 maart tot en met 10 mei. keukenhof.nl






Art Rotterdam keert terug in Rotterdam Ahoy van 27 tot en met 29 maart. Deze gerenommeerde beurs voor hedendaagse kunst is dit jaar verrijkt met een zorgvuldig gecureerde en scherpe selectie fotografie onder de vertrouwde naam Unseen Photo. artrotterdam.com












1
NATIONAAL TINNEN FIGUREN MUSEUM, OMMEN
Duizenden handbeschilderde tinnen figuren brengen historische en fantasierijke scènes tot leven. Klein van formaat, groots in detail.
2
NATIONAAL VLASSERIJ- EN SUIKERMUSEUM, KLUNDERT
Een onverwacht leuk museum over suikerbieten, vlas en het leven eromheen.
3
MUSEUM VAN DE 20 e EEUW, HOORN
Een vrolijke tijdreis langs retrointerieurs, speelgoed en design uit de vorige eeuw. Herkenbaar, nostalgisch en voor alle leeftijden.
4 MUSEUM TOT AMSTERDAMZOVER,
Een sereen en verrassend museum over dood, rituelen en afscheid, waar kunst en cultuur samenkomen.
5
ROTTERDAMSROTTERDAMRADIOMUSEUM,
Voor liefhebbers van techniek en nostalgie: radio’s, zendapparatuur en audio uit vervlogen tijden.

De zestienjarige Jan Dibbets (1941) bezocht samen met zijn klas en tekenleraar een kunstmuseum. Ze bekeken en bespraken werken. De leraar kon ze overal over vertellen. Tot ze bij een klassieke Mondriaan kwamen, een schilderij met rechte lijnen en witte vlakken. De leraar zei: „Dit kunstwerk bewonder ik. Toch kan ik jullie niet uitleggen waarom.” De leerlingen liepen verder, Jan Dibbets bleef staan. Hoe kon zijn leraar die álles wist niet uitleggen waarom hij dit schilderij zo goed vond? Het zaadje voor zijn kunstenaarschap was geplant.
Als zeventienjarige leerde ik mijn eindexamenstof voor het vak Kunstgeschiedenis. Jan Dibbets, met zijn foto’s van horizonnen en vierkanten, begreep ik niet. Toch trokken ze me aan. Konden kijkexperimenten kunst zijn? Niet veel later startte ik mijn studie Kunstgeschiedenis. Soms kan iets dat je niet helemaal begrijpt je vastpakken. Omdat er genoeg is dat je wél begrijpt en er genoeg in zit dat je wil ontdekken. Playing-hard-to-get-kunst. Het is kunst waar je voor moet werken. Ze komen niet naar jou, maar jij moet naar hen. Tot en met 5 april daagt het werk van Jan Dibbets je uit in H’ART Museum.
‘TV as a Fireplace’ heet dit kunstwerk. Een knapperend haardvuur op je televisiescherm is tegenwoordig iets heel gewoons, maar bedenk het maar eens. Jan Dibbets bedacht dit kunstwerk in 1968.
Van 24 tot 31 december 1969 werd het kunstwerk dagelijks uitgezonden op de Duitse televisie aan het einde van de programmering. Een perfecte manier om een nieuw en groot publiek te bereiken!

Sietske van Zanten is directeur van het LAM, gewoon een bijzonder museum, midden in het groen van Landgoed Keukenhof in Lisse. Sietske presenteert regelmatig het televisieprogramma Nu te Zien! Volg het museum op Instagram via @lam_museum, of bezoek lammuseum.nl.
De grote zaal in het H’ART Museum is sowieso al een plaatje, maar is tijdens deze tentoonstelling een topstuk op zich. Jan Dibbets bepaalde waar welk kunstwerk moest komen te hangen, alsof het de compositie van een kunstwerk was.
IN EEN VIDEO VAN NOG GEEN
DRIE MINUTEN GAAT HET
VUUR AAN EN DOOFT HET.
JAN DIBBETS WILDE HET IDEE
VAN HUISELIJKE GEZELLIGHEID
TE KIJK ZETTEN.

TEGENWOORDIG ZIJN ER OVERAL DIGITALE
HAARDVUURTJES TE ZIEN, BIJVOORBEELD OP YOUTUBE.
‘FIREPLACE 10 HOURS FULL HD’ IS ALLEEN AL 159 MILJOEN KEER BEKEKEN.






In de grote solotentoonstelling van Jan Dibbets ‘Toward Another Photography’ in H’ART Museum in Amsterdam zie je de laatste schilderijen die de kunstenaar maakte, een paar installaties en vooral veel van zijn eerste fotowerken. Verwacht geen mooie plaatjes, maar mooie ideeën. Jan Dibbets wilde bewijzen dat foto’s niet de werkelijkheid zijn, maar oogbedriegers.

Perspective Correction –Square in Grass.
Neem deze foto van Jan Dibbets. Je ziet een vierkant in het gras. Toch is de werkelijkheid anders. Jan Dibbets sneed een langwerpige hoekige vorm uit het gras, de onderkant smaller, de bovenkant breder. Door het perspectief lijkt het een perfect vierkant blok.

De do ko Ne on ha Jan Dibbets.
De kunstwerken van Jan Dibbets zijn doordenkertjes en -kijkertjes. Wat ik zei: ze komen niet naar jou,je moet ervoor werken. Neem een extra paar ogen mee, kijk, praat en ontdek hoe mooi een goed idee kan zijn. hartmuseum.nl


KIJKTIP
BIJ ‘NU TE ZIEN!’ OP NPO START LEID IK JE ROND OVER DE TENTOONSTELLING VAN JAN DIBBETS.




























































Na een aantal jaren van schaarste is er weer meer aanbod van sinaasappels. Dat proef je terug in de goede kwaliteit en heerlijke smaak van de 100% sappen van Appelsientje en CoolBest. Zo geniet je extra van een glas puur sap, goed voor energie en weerstand. Samen met onze leveranciers werken we aan lokale projecten die fruitboeren helpen om te voldoen aan onze hoge eisen aan fruit.



„Hij heeft heerlijk geslapen”, hoor je vaak bij het ophalen van je kind. Volgens Maria Rahman betekent dat vooral dat er lang is gehuild, maar dat zeggen ze nooit bij de crèche. In De waarheid achter de kinderopvang beschrijft ze wat ouders wordt beloofd en wat echt achter gesloten deuren gebeurt. „Ik noem het een regime.”
1
Wiebenje,enwaarom spreekjejeuit?
„Ik ben moeder van een dochter van dertien en een zoon van zeven. Sinds 2020 werk ik in de kinderopvang (niveau 4) en ook als slaapcoach. Ik werkte op meerdere locaties, ook als zzp’er. Daarom spreek ik me zo stellig uit over de misstanden: dit is namelijk niet iets van één plek.”
2
Watkrijgenouders tezien,enwat gebeurterzodra zededeuruitzijn?
„Tijdens een rondleiding krijgt je kind een knuffel, omdat jij erbij bent. Maar zodra je weg bent, wordt het kind neergelegd en draait het schema door. Dan is het niet meer: wat heeft dit kind nu nodig? Dan is het: wat moet er gebeuren? Fruit snijden, flessen, verschonen, opruimen. Dat schema is zó strak dat je nauwelijks tijd hebt om er echt te zijn voor kinderen. En dan wordt het: stil nu, ophouden met huilen! Ik noem het echt een regime.”
3
Watgebeurter metbaby’sdie veelhuilen,als deouderswegzijn?
„Die ‘lastige’ baby’s worden meteen op bed gelegd. Dat is
een ongeschreven regel: laat maar, dan blijft de groep rustig. Maar wat leert een baby dan? Ik huil en niemand komt. Ze raken overprikkeld en vallen soms in slaap van stress, niet van moeheid. En ouders horen dan: ze heeft lekker geslapen. Wat ze er niet bij zeggen: ze heeft eerst drie kwartier liggen huilen. Dat is super super zielig. Er zijn echt wel pedagogisch medewerkers die wíllen knuffelen, maar de tijd laat het niet toe.”
4
Watzijnde voorbeelden
waarvan ouders denken: dit kan toch niet?
„Kinderen worden vastgebonden omdat ze uit de stoel klimmen. Kinderen vallen en dat wordt niet verteld, of er wordt iets anders van gemaakt, terwijl een kind een hersenschudding kan hebben. Als ze niet luisteren, worden ze hard vastgepakt of meegetrokken. Kinderen die wat meer poepen, die ‘stinken’, worden al bij voorbaat gehaat. Dan hoor je: Jij vies kind. Dat is gewoon pesten.”
5
Wat kunnen ouders doenalszetwijfelen?
„Haal je kind eens onverwacht eerder op. Bel tussendoor. Vraag om een foto. En ik ben voorstander van
camera’s waarmee ouders mee kunnen kijken. En let ook op signalen als onrustig slapen, schrik bij het eten, rare blauwe plekken, ander gedrag. Neem jouw gevoel serieus. En dien officieel een klacht in als blijkt dat het niet klopt.”
6
Wanneerwistje: ikmoetditgaan opschrijven?
„Een paar jaar geleden zei ik al tegen ouders: dit gebeurt er met je kind. Maar ik durfde niet door te pakken. Ik was een alleenstaande moeder. Ik werd gewaarschuwd met: dan kom je nergens meer aan de bak. Later sprak ik ouders en die zaten nog steeds in therapie, kinderen ook. Ik wil geen onderdeel meer zijn van dit systeem.”
7
Waarvechtjijvoor?
„Dat dit stopt. Dat de groepen kleiner worden en ouders betere begeleiding krijgen. Ze betalen grof geld en hebben recht op de waarheid. Heel eerlijk: ik werd er zelf ziek van. Deze problematiek moet naar de politiek. Daarom blijf ik praten.” ■
Volg Maria op TikTok: mariarhmnx

schreef een ontluisterend boek.

‘Wat ouders NIET te horen krijgen...’


























































ij elke trouwfoto zat een tekstje. Soms drie regels, soms een halve brief. En bijna niemand schreef: alles klopte. Het ging juist over wat er misging, of net niet volgens plan liep. De bolero die je nog snel kocht omdat je jurk ineens toch te bloot voelde. Het kapsel dat het niet redde tegen windkracht zes. Regen die
Na de oproep voor trouwfoto’s kwam er geen keurige selectie binnen, maar een hele stoet. Van net begonnen liefdes tot huwelijken die al een leven meegaan. Een kasteel in Rhoon, Disneyland Parijs, het Rotterdamse stadhuis. Een ja-woord op een boot door Amsterdam, op het strand in Gambia, en zelfs iemand in een A-Ford uit 1928.




precies viel tijdens het ja-woord, zodat je maar één ding kon doen: lachen, en weer dóór. En dan kijk je naar die foto en zie je het meteen. Wie overal bovenop zat. Wie zichzelf naast de bruid had geparkeerd en daar ook geen plannen meer had om weg te gaan. Wie de blik had van




Onze ouders Ben en Yvonne zijn al vijftig jaar getrouwd. Op 24 december vierden zij die mijlpaal samen met ons. Van hun trouwdag tot nu: we zijn dankbaar dat we deze liefde al zo lang van dichtbij mogen meemaken. Wendy en Ton






iemand die al een uur weg wil, maar beleefd genoeg is om nog even te blijven. Het zijn ook tijdcapsules. Kapsels die zo hoog moesten dat je je afvraagt hoe iemand in de auto is gekomen.




Jurken die eerst pof waren, toen strak moesten, en nu weer ergens ertussenin hangen.
Champagnetoren
Juist omdat die foto’s uit zoveel verschillende jaren komen, zie je ook wat er is verschoven. Niet alleen de jurken, vooral het moment waarop mensen trouwen. Vroeger trouwde je jong, omdat dat nou eenmaal was wat je deed. Nu bouwen mensen vaker eerst samen een leven op, en denken pas daarna: zullen we het ook officieel maken? Eerst studeren, werken, reizen, een beetje






4.040 scheidingen bij. Begin jaren 2000 zat je nog ruim boven de dertigduizend huwelijken per jaar die stukliepen. Nu hangt het al een tijd lager en stabieler. De verklaring is deels simpel: er wordt minder getrouwd. En deels onzichtbaar: een hoop stellen gaat uit elkaar zonder ooit te trouwen, dus die breuk zie je niet terug in


Deze foto is van onze trouwdag op 4 september 1970. We zaten samen bij fanfare Fusica in Naaldwijk. Zo werden we ingehaald bij de kerk. Inmiddels zijn we dus 55 jaar getrouwd! Piet en Paula Grootscholten


ging. Intussen is de bruiloft zelf steeds minder ‘datum prikken en klaar’ en steeds meer een project.


uitzoeken wie je bent. En pas daarna kijken of je zin hebt in een ring en een champagnetoren. Dat zie je terug in de cijfers. In 1970 trouwden 123.631 stellen. In 2024 waren dat er 68.682. En wie wél iets wil vastleggen, maar niet per se klassiek, kiest steeds vaker voor een geregistreerd partnerschap: 24.805 stellen in 2024.
Minder romantisch
Bij diezelfde cijfers hoort ook de minder romantische kant. In 2024 eindigden 25.386 huwelijken in een scheiding. Dat is zo’n 7,5 scheidingen per duizend huwelijken. Bij geregistreerde partnerschappen kwamen er

Ton en Ria Loos-van Wouw: zestig jaar getrouwd.
de huwelijkscijfers. En ja, dat ‘proefrijden’ (eerst samenwonen, dan trouwen) helpt ook mee. Daardoor ligt de scheidingskans na tien jaar huwelijk nu grofweg rond 25 tot 30 procent, waar dat vroeger eerder richting 40 procent

Iedereen wil persoonlijk, niemand wil standaard, en dat betekent in de praktijk vaak: veel keuzes, veel meningen, veel overleg. Eén avond scrollen en je ontdekt dat je blijkbaar iets moet vinden van lettertypes, looproutes, servetten en het exacte moment waarop je binnenkomt. Daar past de opkomst van de weddingplanner eigenlijk naadloos bij. Niet als luxe, maar als buffer. Iemand die het gedoe opvangt, de lijstjes bewaakt en voorkomt dat de appgroep ‘Hoera wij
➜

n

Hierbij een foto van 54 jaar geleden. Wij zijn nog steeds gek op elkaar! Jan en Lia Righarts
zijn



gaan trouwen’ eindigt als een familieruzie over de tafelschikking.
Dan komt de modewereld ook nog even langs met een lijst. Vogue gooide de trouwtrends voor 2026 op een hoop; het ziet er gelikt uit en het is zelden goedkoop. Maar als je door de glitters heen kijkt, staat er vooral iets eenvoudigs: je hoeft niet alles. Niet én een groot binnenkomstmoment, én een champagnetoren, én een fotohokje, én een bloemenwand, én vuurwerk, én een act, én een afterparty. Want je kunt een bruiloft inderdaad stuk plannen. Terwijl het meestal op drie dingen aankomt die de avond dragen: eten dat klopt, muziek die mensen laat blijven, en een setting waarin niemand halverwege afhaakt.
Mooie bruidstaart


Op 14 oktober 2025 zijn wij met ons hele gezin naar Ibiza gegaan om daar te trouwen. Het was een fantastische en onvergetelijke dag.



En dan zijn er nog de dingen die je zonder drama kunt laten. De taart waar niemand aan durft te komen omdat hij te mooi is, werkt vooral op foto’s. Dessert mag ook gewoon iets zijn dat opgaat. En wie iets wil bewaren, kan beter kiezen voor iets wat je later echt nog opent: een doos met

Mijn ouders, Henk en Cis Mark, waren op 9 februari 2026 maar liefst 65 jaar getrouwd. Kijk vooral even naar het gezicht van het bruidsmeisje. Manon Groepenhoff-Mark

We trouwden in 1998, ondanks 24,5 jaar leeftijdsverschil. Mijn vrouw is overleden, maar ik had haar nooit willen missen.
kaartjes, polaroids, een fotoboek achteraf. Het gastenboek met snelle krabbels verdwijnt toch weer in een la, ergens bij die ene trouwfoto die je jaren later ineens terugvindt en dan misschien wel opstuurt naar DenD.


as ve Da wa t en onv

Daniëlle en Willem
Waar gaat al dat geld toch heen?



Ik ben sinds 7 jaar weduwe en heb 4 jaar geleden Hans leren kennen. Hij kwam als handwerker bij mij helpen. Omdat het gezelliger is met z’n tweeën in Oostenrijk, waar ik sinds 2007 woon, dan alleen, hebben we besloten onze patchworkfamilie samen te voegen. We hebben het gevierd met onze vier kleinkinderen en veel vrienden.


Myriam Resetschnigde Bruijn




Een gemiddelde bruiloft bestaat niet, maar grofweg dit: met tachtig tot honderd gasten kom je vaak uit rond €20.000 tot €30.000, zonder huwelijksreis. Met vijftig gasten zit je eerder tussen €7.500 en €12.000. Ga je lang door en wil je alles erop, dan schiet je richting €30.000 tot €40.000 euro. Het loopt zo op omdat bijna alles per persoon gaat. Eten en drinken zijn de grootste post: reken €50 tot €150 per gast, afhankelijk van hoe uitgebreid je het maakt. De rest zit in een paar vaste kosten: locatie, fotograaf, muziek en styling. japon, trouwpak en ringen komen daar vaak nog bovenop. En dan is er nog het gemeentehuis, dat per gemeente enorm kan verschillen: van een paar honderd euro tot boven de €1.000 voor een populair moment. Gratis kan soms nog, meestal maandagochtend en zonder poespas. ■


Kane stopt definitief, maar Dinand Woesthoff niet. Hij gaat dóór! Als coach in The Voice of Holland. Het programma kon na alle commotie over grensoverschrijdende gedragingen niet nóg een rel gebruiken. Maar Dinand zorgt wél voor ophef. De reacties? Van ‘arrogante klootzak’ tot ‘ondertitelen graag’.
Zelden was de kritiek zo eendrachtig.
Dinand: „Ik vind het wel grappig.”
gramma kon na alle commotie hrijdende niet ken. Maar Dinand wél acties? Van ertitelen tiek zo et wel

1998: Richt Kane op met gitarist Dennis van Leeuwen. Zijn studie bouwkunde hangt hij aan de wilgen. De doorbraak volgt met Where Do I Go Now.
1999–2003: Kane scoort hits als Rain Down on Me.

2004: Overlijden van zijn vrouw Guusje. Brengt Dreamer (Gussie’s Song) uit als tribute. Later volgt ook het Woezel en Pip-imperium.
2005–2014: Kane scoort meerdere platina-albums en tours. De band stopt in 2014 na een afscheidstour.




2015–2022: S l oloo-
projecten, waaronder Whatever Comes For Me (2021). Ook gastoptredens en werk voor film en tv.
2021: Solo-album Luck of Birth.
2023–2025: Kanereünie met nieuwe shows en muziek. Band stopt opnieuw in 2025.
2026: Debuteert als coach bij The Voice of Holland, naast Ilse DeLange, Willie Wartaal en Suzan & Freek.


Over alle kritiek: „Ik vind het wel grappig”

„Ik ben een sociale egoïst, ik volg mijn eigen pad”
„Al van jongs af aan leef ik vanuit mijn hart. Ik kon als kind al intens genieten van het zonlicht dat op een boomblad viel”




„Met alle respect: ik vind dat een soort zweefteef. Als je die op Instagram volgt, dan denk je van: watdoetdiemaningodsnaam?”




„Zou Dinand weten dat z’n hoed andersom hoort, of vindt hij het als zuidwester leuker staan..?
#TVOH #TheVoice #TheVoiceOfHolland”
„Dinand praat vooral graag over zichzelf, het liefst met allerlei ingewikkelde Engelse termen. Ik ben benieuwd of hij de kandidaten überhaupt ziet.”



„Gaat de man die zelf zingt als een vals afgestelde sirene anderen zangles geven?”


„Mijn vrouw Lucy is zo’n vrouw over wie al die liedjes gaan die ik vroeger nooit begreep”

„Ik lieg niet, dat heb ik mezelf afgeleerd”





ECHTE NAAM: Dinand Woesthoff (voluit: Marco Frank Ferdinand Woesthoff)
GEBOREN: 6 september 1972, Gorinchem
BEKEND VAN: Kane, solo, The Voice of Holland (coach, seizoen 13)



„Ik heb nog nooit zo’n arrogante klootzak gezien. Wat een griezel van een gozer.”



GEZIN: zoon Dean met Guusje Nederhorst. Met Lucy Hopkins: zoons Jimi en Che, en dochter


Dinand met partner Lucy.

„Toen ik stopte met Kane wist ik niet wat mij te wachten stond. Ik ging van een leven als kapitein op een piratenschip naar een man die dagelijks in de file stond”

Ze gingen in 2021 naar Ibiza om ‘zelfvoorzienend’ te leven. In hun wereld betekent dat: een villa met zeezicht, zwembad en alle gemakken, ooit gekocht voor €2,2 miljoen. En nu gaat het gezin alweer door. Volgende halte: Noord-Engeland, waar Lucy haar wortels heeft en waar ze een cottage willen verbouwen tot nieuw thuis.
Gevraagd waar hij te veel geld aan uitgeeft, is Dinand helder: „Aan onze verbouwing in Engeland. Op afstand verbouwen is tricky. Het ook nog heel goed willen doen, is dubbel tricky. Dubbel duur.” Na jaren ‘ik-ikik’, is Lucy hiermee ineens aan de beurt. In een grammaticaal ontspoorde ode aan haar op Insta zegt hij: „Dankjewel voor alle keren dat ik aan stond en jij dus veel te vaak gedimd.” (...) „Englandonthehorizon MissHopkins.Can’twait.”









































Monica Geuze begon was ooit dat negentienjarige meisje dat besloot over haar leven te vloggen. Vandaag de dag is ze één van de grootste van Nederland. Ze heeft rond de 2 miljoen volgers op Instagram, een stevige TikTok-achterban, presentatieklussen bij Love Island, Temptation Island: Love or Leave en De Bachelorette, een plek bij The Masked Singer en haar eigen beautymerk Sophia Mae. Monica deelt lief en leed alsof je erbij zit. En drie stories later duikt er weer een splinternieuwe Chanel-tas op. Ze vliegt de wereld over, maar weet het dan nog te brengen als: kijk mij eens gewoon doen.
In de belangstelling


Monica Geuze wordt deze maand 31. Ze is al jaren overal, maar één opmerking van haar kan nog steeds een hele branche laten flippen. Zoals onlangs, toen het ging over haar… nagels.







Hoezo gewoon? Ze is altijd spraakmaned! Op TikTok vertelde ze onlangs dat ze stopt met BIAB-nagels (nagelverlenging). Ze waarschuwde voor acrylaatallergie door gelproducten: „Dan kun je later misschien geen kunstheup meer krijgen als je die nodig hebt.” Gevolg: klanten schrokken, afspraken werden geannuleerd, stylisten raakten omzet kwijt. De nagelbranche verdedigde zich met uitlegvideo’s en opnieuw stond Monica in de belangstelling.
Wie zijn
nog meer jarig?




NIKKIE DE JAGER
Presentatrice en visagiste 2 maart, 32 jaar



GUUS MEEUWIS
23 maart branche belangstelling ■ S Zanger maart, 54 jaar






















KLAASJE MEIJER
K3-aangeres 2 maart, 31 jaar







YOLANTHE CABAU
Actrice en presentatrice 19 maart, 41 jaar





PATTY BRARD
Presentatrice25 maart, 71 jaar

door Savanna Bosch


RAM 21 maart - 20 april
Je energie trekt aan en je wil vooruit, maar niet alles hoeft meteen. Op werk kom je verder door keuzes af te maken in plaats van nieuwe te starten. Relaties profiteren van rust in je communicatie. Financieel is dit een goede periode om impulsieve beslissingen even te parkeren en eerst te kijken wat echt nodig is, Ram. Neem ook de tijd om je eigen grenzen te voelen, zodat je energie op de lange termijn behouden blijft.
STIER 21 april - 21 mei
Je voelt behoefte aan stevigheid en overzicht. Dat werkt door in huis, werk en relaties. Kleine aanpassingen leveren meer op dan grote plannen. Financieel is dit een moment om vaste lasten te bekijken en te vereenvoudigen. Tijd nemen voor wat vertrouwd voelt geeft rust en maakt ruimte voor wat straks groeit.
VISSEN
20 februari - 20 maart
Je beweegt van binnen langzaam mee met het licht dat terugkomt. Je intuïtie is scherp, maar vraagt ook om grenzen. In relaties helpt het om duidelijk te zijn over wat van jou is en wat niet. Werk vraagt om structuur, niet om meebewegen. Creativiteit geeft rust, zolang je jezelf niet verliest. Reflectie en zelfzorg zijn belangrijk; kleine rituelen brengen evenwicht. Luister naar je emoties, ze wijzen je vaak de juiste richting.
WEEGSCHAAL 24 september - 23 oktober


TWEELINGEN 22 mei - 21 juni
Je zoekt evenwicht tussen plannen en rust. Sociale contacten geven energie, maar vragen ook om grenzen. Op werk werkt samenwerking goed als je duidelijk bent over je rol. Financieel is het verstandig om keuzes te maken in plaats van alles open te houden. Je voelt je sterker als je besluitvaardig durft te zijn. Evenwicht en diplomatie zijn je kracht; wees bewust van je energie en neem tijd voor reflectie. Positieve interacties inspireren je.
SCHORPIOEN 24 oktober - 22 november


Je hoofd draait snel en je omgeving beweegt mee. Gesprekken brengen nieuwe inzichten, zolang je ook luistert. Op werk is focus nodig om ideeën concreet te maken. Relaties worden helderder door afspraken uit te spreken. Financieel loont het om details te checken. Minder tegelijk doen geeft verrassend veel ruimte. Verbinding met anderen inspireert je, maar vergeet niet je eigen grenzen te respecteren.
KREEFT 22 juni - 22 juli
Je behoefte aan veiligheid en overzicht neemt toe. Dat vraagt om keuzes, niet om terugtrekken. In relaties helpt het om verwachtingen uit te spreken voordat ze zich opstapelen. Werk vraagt om duidelijke grenzen. Financieel is overzicht belangrijk, vooral bij kleinere uitgaven. Rust ontstaat als je jezelf niet steeds weer verantwoordelijk maakt voor alles.
LEEUW 23 juli - 22 augustus
Je krijgt weer zin om zichtbaar te zijn en initiatief te nemen. Dat pakt goed uit als je ook oog houdt voor samenwerking, Leeuw. Relaties vragen om balans tussen geven en ontvangen. Op werk kun je iets laten zien waar je al langer aan werkt. Financieel ontstaat ruimte door bewust kiezen, niet door laten lopen. Creativiteit en passie komen tot uiting als je anderen inspireert. Zorg dat je grenzen bewaakt.
MAAGD 23 augustus - 23 september
Je hoofd wordt helderder en je krijgt grip op zaken die eerder bleven liggen. Werk leent zich voor afronden en structureren. Relaties profiteren van minder analyse en meer delen. Financieel is dit een goed moment om te vereenvoudigen en overbodige kosten te schrappen. Rust komt uit overzicht, niet uit perfectie. Plan realistisch en wees mild voor jezelf; kleine stapjes leiden tot groot resultaat, Maagd. Organisatie en helderheid brengen onverwachte voldoening.
Je ziet scherp wat wel en niet werkt. Dat geeft kracht, zolang je niet alles op scherp zet. Op werk kun je iets oplossen dat al langer speelt. Relaties vragen om eerlijkheid zonder controle. Financieel is het slim om oude afspraken te checken. Loslaten geeft ruimte, ook al voelt dat spannend. Intense focus helpt je diepgang te vinden, maar ontspanning is essentieel. Vertrouwen en openheid bevorderen diepe verbindingen en inzichten. Geduld en doorzettingsvermogen helpen je doelen te realiseren.
BOOGSCHUTTER 23 november - 21 december
Je blik richt zich naar buiten en vooruit. Plannen maken geeft energie, maar vraagt ook om realisme. Op werk loont het om te kiezen en niet alles open te laten. Relaties profiteren van aanwezigheid in het moment. Financieel is matiging verstandig. Beweging en frisse lucht helpen je hoofd helder te houden.
STEENBOK 22 december - 20 januari
Je voelt de drang om zaken vast te leggen en structuur aan te brengen. Werk biedt kansen als je zichtbaar maakt wat je doet. Relaties worden lichter als je niet alles draagt. Financieel is dit een goed moment voor duidelijke afspraken. Ontspanning ontstaat als je jezelf niet alleen op resultaat beoordeelt. Geduld en doorzettingsvermogen helpen je doelen te realiseren.
WATERMAN 21 januari - 19 februari
Je blik staat vooruit en je voelt dat er ruimte ontstaat om dingen anders te doen. Oude patronen verliezen hun grip. In relaties en werk werkt eerlijkheid verhelderend, vooral als je niet alles relativeert met humor. Financieel loont het om overzicht te houden. Een idee dat al langer sluimert, verdient nu aandacht en uitvoering. Nieuwe kansen lijken te verschijnen uit onverwachte hoeken. Vertrouwen in jezelf helpt hierbij.


















































































































































Schaam je er niet voor, stel je vraag aan Lieve. Ze helpt je! lieve@dend.nl.
Lieve Lieve,
Mijn vriend leerde me kennen in een nachtclub. Ik was dronken, droeg een crop top en een netpanty en voelde me vrij. Dat beeld is blijven hangen. ,,Zo vond ik je leuk”, zegt hij soms. Half als grap, half serieus. Nu wil ik minderen met alcohol. Misschien zelfs stoppen. Maar met wijn ben ik volgens hem leuker en losser. Hij vult mijn glas bij zonder te vragen. Als ik nee zeg, verzucht
lieve@dend.nl.
hij: 'Doe niet zo braaf.' Wat me pijn doet: hij raakt me pas echt aan als ik heb gedronken. Alsof hij wacht tot ik weer die versie ben van toen. Ik vraag me af of ik ben veranderd, of dat dit gewoon niet klopt. A., uit E.
Dit is geen gezelligheidsprobleem, maar een beeld dat hij maar niet wil loslaten. Hij werd verliefd op jou in de nacht, aangeschoten en zonder

Beste Lieve, Vijf jaar geleden werd ik verliefd op een vrouw die twintig jaar jonger is dan ik. Bijna even oud als mijn jongste dochter. Ik voelde me weer gezien en vertrok bij mijn gezin, ervan overtuigd dat iedereen het wel zou verwerken. Dat gebeurde niet. Mijn kinderen praten nauwelijks met me, mijn ex wil me niet zien en mijn nieuwe relatie bestaat vooral uit ruzie en wantrouwen. Ik heb
rem. Die versie van jou blijft hij zoeken, terwijl jij intussen bent veranderd. Je weet beter wat je wilt, je wilt minder drinken en meer jezelf zijn. Dat heet groei. Dat hij liever heeft dat jij jezelf een beetje dempt om aantrekkelijk te blijven, is een duidelijk signaal. Als hij vooral die ene nacht blijft missen, dan is hij verliefd op een herinnering. En daar kun je hooguit een kater aan overhouden, geen relatie.
spijt, maar ook het gevoel dat ik niet meer terug kan. Heb ik dit verkeerd ingeschat of hoort dit erbij?
M., uit H.
Je koos voor passie en dacht dat de rest wel zou bijtrekken. Slecht nieuws: dat doet het niet. Liefde met leeftijdsverschil is geen probleem, doen alsof je gezin dat wel even slikt wel. Dat is een optimistische eigenschap, maar geen slimme. Je kinderen zagen geen liefdesverhaal maar een vertrek. Je nieuwe partner kreeg geen frisse start, maar een man met schuld en spijt. En jij zit ertussen, verbaasd dat het niet gezellig wordt. Dit is geen fase, dit is het gevolg van hoe je het hebt aangepakt. Sommige keuzes blijven rommelig.
Je kunt gek op elkaar zijn en tóch langs elkaar heen vrijen. De één wil vaker. De ander minder. De één zoekt spanning, de ander vooral rust. Dat heeft niks te maken met liefde, maar alles met verschil. Vaak wordt het opgelost met inslikken. Jij gaat mee terwijl je eigenlijk geen zin hebt. Of je houdt je verlangen voor jezelf om de boel niet op scherp te zetten. Even werkt dat, maar daarna sluipt de irritatie erin. Seks voelt als móeten. Of juist als tekort schieten. Het lastige is: verlangen laat zich niet afdwingen. Je kunt liefde bespreken, maar 'zin' niet onderhandelen. Je kunt erover praten tot je moe bent, maar sommige verschillen blijven. Dat betekent niet dat iemand fout zit. Soms is de conclusie simpel en pijnlijk tegelijk. Jullie passen niet bij elkaar in bed. Dat is geen falen. Dat is eerlijk kijken naar wat er wél en niet klopt.
OOK EEN SEKSTIP? Mail naar: lieve@dend.nl





Hoi Lieve,





Mijn vriend noemt zichzelf eerlijk. Ik noem het inmiddels commentaar. Op mijn kleding zegt hij dingen als: 'Dapper jurkje' of 'Dit doet niks voor je figuur.' Als ik me mooi voel, zegt hij dat ik er moe uitzie. In gezelschap verbetert hij me. 'Zo was het niet' of 'Je vertelt het weer raar.' En toch blijft hij me af en toe geven wat ik nodig heb. 'Vandaag zag je er wél leuk uit.' Net genoeg om te blijven. Als ik afstand neem, noemt hij me kil. Hij zegt dat hij dit doet omdat hij van me houdt. Maar ik herken mezelf niet meer. Ligt dat aan mij?
S., uit G.
Nee. En je voelt dat zelf ook. Dit is geen botte eerlijkheid, dit is langzaam bijslijpen tot je past. Kleine opmerkingen, kleine correcties, af en toe een aai over je bol. Zo raak je jezelf kwijt zonder dat je het doorhebt. Liefde hoort je

voel,



niet te laten twijfelen aan wie je bent. En iemand die je kleiner maakt en dat liefde noemt, is geen veilige plek om te blijven. ■
doet niks voor je figuur’
























Laat ons weten wát en waarom jij verzamelt!
Verzamelen is de allergrootste hobby van Nederland. Miljoenen landgenoten vinden het leuk om een verzameling aan te leggen van de meest uiteenlopende zaken. Van inderdaad postzegels, pokémonkaarten, voetbalshirts, landkaarten, vlaggen en andere ditjes en datjes. Verzamel je ook? Zet dan een gratis oproep in DenD. Mail naar: post@dend.nl









Ze wa me In w Fo leid had g e. Maa een werksc wanneer er
R va bo Da pa






Voor onze verzameling historische Erres-radio’s uit de jaren '20 en '30 zoeken wij nog spaarpotjes, collectebusjes of missiebusjes van omroepverenigingen, vooral van de VARA en de IKON. Radiobodes uit die periode zijn ook welkom. Daarnaast hebben we interesse in oude Erres-radio’s uit die tijd. Uiteraard tegen vergoeding en/of verzendkosten. Teun en Jany Terlouw, Barendrecht terlouw1956@gmail.com





Ze waren ooit overal: op tv, in de bladen, op rode lopers met kapsels waar geen krul verkeerd zat. En toen: stilte.
In onze rubriek Was dat niet die van…? duiken we in het post-glamourleven van vergeten sterren. Deze maand: ANITA DOTH (54) van 2 Unlimited...
Anita Doth is zo’n naam die je meteen teruggooit naar de jaren negentig. 2 Unlimited was een wereldmachine, met hits als Get Ready For This, No Limit en Twilight Zone. „Eigenlijk leidde ik vrij plotseling het leven waarvan ik altijd had gedroomd: het leven van een popster”, zegt ze. Maar het tempo was slopend: „Dan kregen we een werkschema van honderden optredens en vroeg ik wanneer er tijd was om vakantie te nemen en uit te rusten. Dan werd ik als ‘lastig’ gezien.” Tussen 2 Unlimited-wederhelft Ray Slijngaard en Anita rommelde het geregeld, en rijk is ze er ook al niet van geworden: „Ik heb geen miljonairsleven.” Anita, die tot twee keer toe borstkanker kreeg, duikt nog altijd op bij festivals, trad op met Diva’s of Dance en gaf les aan de Herman Brood Academie. En optreden blijft haar passie: „Zingen, performen is nog altijd mijn lust en mijn leven.”
Dan werd ik als ‘last



KAN MIJ HELPEN AAN BORDUURPATRONEN?
Ik ben op zoek naar borduurpatronen. Als er kosten aan verbonden zijn, betaal ik die natuurlijk. Ik zou er echt heel blij mee zijn.
Corry Puijk toncorry@casema.nl





WIE HEEFT NOG SPONGEBOBSPULLETJES?
Roan is 15 en heeft een verstandelijke beperking en autisme. De puberteit is hier best pittig, dus er is veel spanning. Zijn grote houvast op dit moment is SpongeBob. En dan vooral Sandy. Daar fleurt hij zo van op. Hij neemt zelfs een foto van Sandy mee naar bed, gewoon om te kunnen ontspannen. Heeft iemand nog stickers, kaartjes, plaatjes of kleine SpongeBob/ Sandy-spulletjes liggen waar je niks meer mee doet? Daarmee maak je Roan ontzettend blij. Esther van Santen
Zwanenbalg 1323 1788 ZC Julianadorp





90 en niet te stoppen:



1 A KNIGHT OF THE SEVEN KINGDOMS (HBO Max)
2 HIS & HERS (Netfl ix)
3 THE NIGHT MANAGER, SEIZOEN 2 (Prime Video)

Ik speel graag samen met mijn moeder van 90 het spel Mens erger je niet Pesten. We hebben er al jaren plezier van, maar ons exemplaar is inmiddels helemaal versleten. Heeft iemand dit spel nog liggen en mag ik het misschien overnemen? Renate Bovens rbovens@gmail.com





*** Podcast van de maand ***
DE BARON DIE NOOIT BESTOND
Dagblad van het Noorden duikt in het spoor van Rob Jacob, een man die zich voordoet als baron of miljonair. Interpol zoekt hem, zijn slachtoffers ook, maar hij lijkt spoorloos verdwenen.









Als u wilt reageren op de verhalen in DenD, of als u iets speciaals zoekt voor uw verzameling, dan kan dat via het volgende e-mailadres: post@dend.nl
Ga voor oplossingen van de puzzels naar: ditjesendatjes.nl/puzzel en voor de prijzen naar: ditjesendatjes.nl/winnen
Ons redactieadres voor brieven en kaarten is: DenD
Donauweg 10 1043 AJ Amsterdam




























































Bedankt dat wij jouw favoriet mogen zijn. Het meest verkochte pizzamerk van Nederland.*





van de MAAND

door Annemarie de Haan Gedragstherapeut voor honden







Richting lente verandert de wereld om ons heen langzaam. De dagen worden langer, de temperatuur stijgt en bloemen en bomen komen tot bloei. Veel honden worden actiever en nieuwsgieriger. Ze snuffelen uitgebreid, rennen graag door het gras en volgen sporen van dieren die in de buurt leven.

De 'friends' van Jennifer zijn vaak viervoeters.
Jennifer Aniston werd niet verliefd op een tegenspeler, maar op een hond. Tijdens een Friends-scène waarin Joey en Chandler baby Ben kwijtraken, liep een hondenuitlater langs. Eén hond sprong eruit. „Ik werd op slag verliefd”, vertelde Jennifer. Hij heette Norman, was koppig, luisterde nergens naar en stond op het punt te worden afgeschreven. Aniston nam hem mee naar huis. Norman bleef haar alles tot zijn dood in 2011. „Noem zijn naam en ik voel het meteen”, vertelde ze. Inmiddels heeft Aniston drie honden: Clyde, Lord Chesterfield en Sophie. Clyde, een schnauzer-mix, werd de inspiratie voor haar kinderboeken en het Clydeo Fund. Clyde ging zelfs met haar mee naar een tv-show. Bij Jimmy Kimmel zat hij naast Jennifer in de studio, als haar date voor de avond. Lord Chesterfield, een labrador-mix, adopteerde ze in 2020. Sophie, een pitbull-mix, komt niet vaak in beeld, maar hoort er net zo goed bij.

Maak het leuker en slimmer door nieuwe routes te lopen en je hond af en toe te laten zoeken. Verstop een snack in het gras of neem een speeltje mee dat hij pas halverwege krijgt. Dat geeft mentale uitdaging zonder dat je meteen kilometers hoeft te maken. Houd ook rekening met de drukte. In de lente zijn er meer honden, joggers en kinderen buiten. Voor sommige honden kan dit spannend of stressvol zijn, vooral als er loopsheid in de buurt is.
Opwinding en frustratie
Loopsheid trekt vaak veel aandacht van andere honden en kan leiden tot meer opwinding of frustratie. Neem wat meer afstand, neem desnoods een omweg en begeleid je hond rustig.





Hooikoorts bij honden ontstaat door een allergische reactie op pollen van bomen, gras of bloemen. Symptomen kunnen variëren: jeukende ogen, niezen, tranende ogen, krabben of een rode huid. Ook de poten kunnen geïrriteerd raken door contact met pollen. Niet elke hond reageert hetzelfde; sommige honden hebben alleen lichte klachten, anderen zijn duidelijk ongemakkelijk. Je kunt verlichting bieden door na wandelingen ogen en poten af te spoelen, de vacht goed te borstelen en eventueel overleg met de dierenarts te hebben over ondersteunende middelen.





Geniet samen van langere wandelingen engeuren!nieuwe
Daarnaast kunnen pollen hooikoortsachtige klachten veroorzaken bij honden, zoals jeukende ogen, niezen of huidirritatie. Controleer na elke wandeling de ogen en poten en spoel deze eventueel af. Ook insecten zijn actiever in de lente, dus bescherming tegen teken en muggen is belangrijk.
Stimulatie
Door de lente bewust te benutten voor fysieke en mentale stimulatie, rekening te houden met andere honden, loopsheid en allergieën, blijft je hond gezond, alert en betrokken. Zo geniet je samen van langere wandelingen en nieuwe geuren, terwijl jullie band sterker wordt. ■
Bij wolven en primitieve hondenrassen is het voortplantingsritme vaak seizoensgebonden, waardoor de meeste nesten in de lente geboren worden. Bij gedomesticeerde honden is dit ritme veel minder strikt. Teven kunnen het hele jaar door loops worden, meestal ongeveer twee keer per jaar, met tussenpozen van zes tot acht maanden. Soms valt één van die cycli rond de lente, waardoor het lijkt alsof loopsheid seizoensgebonden is. Het is dus vooral individueel en hormonaal bepaald, en kan per hond verschillen in duur, intensiteit en gedrag tijdens de loopsheid.












Loulou en Vince, zus en broer, zijn Heilige Birmanen van anderhalf jaar oud. Als baby waren het al ondernemende boefjes, en dat zijn ze nog steeds. Loulou (het poesje met de streepneus) kauwt graag op diadeems om te kijken hoe die smaken, Vince (de kater met zijn volle vacht) sleept geregeld Barbiekleertjes in zijn etensbakje en probeert altijd in de lege vaatwasser te klimmen. Maar hun állergrootste hobby is knuffelen! Zodra je de kamer binnenkomt geeft Loulou je kopjes, staand op haar achterpoten, als een stokstaartje. Vince spint nergens harder dan op schoot. Als we ‘s avonds thuis komen, wachten ze ons op van achter het keukenraam, omdat ze ons al van ver horen aankomen.


Ook met uw huisdier in DenD? Mail naar post@dend.nl




Veel honden eten in dit seizoen meer gras. Het jonge gras is sappig en ruikt sterk, wat het extra aantrekkelijk maakt. Daarnaast kan het extra vezels geven of helpen bij een onrustige maag. Na de winter zijn grasvelden ook voller van vers groen en interessante geuren van dieren of insecten. Hierdoor wordt gras eten aantrekkelijker en meer een onderdeel van het verkennende en onderzoekende gedrag van je hond. tinleygedragstherapie.nl

















































Milka Alpenmelkchocolade met Lotus Biscoff® biscuit crumble
























* en andere prijzen. Kansspel geldig in Nederland tot 19/07/2026.
KINDERBOEKENTOPPER








Kintsugi: Sommige dingen zijn mooier als ze eerst gebroken zijn


Evol n,


en feelgood coming-of-ageverhaal over een zomer vol verandering. Omdat hun ouders een relatie hebben, moeten Laura en Bowen in één huis gaan wonen. Laura zit niet echt te wachten op een stiefbroer. Zeker niet als blijkt dat haar beste vriendin Bobbie hem wel ziet zitten. Bowen is gezakt voor zijn eindexamen, terwijl zijn klasgenoten gaan studeren. Kortom, er is veel aan de hand. Weten Laura en Bowen elkaar te vinden in deze zomer vol verandering? Het verhaal gaat over dingen die veel tieners herkennen: verliefd zijn op iemand waar het ingewikkeld mee is, gedoe met vriendschap, onzekerheid, en dat moment waarop je merkt dat je leven ineens een andere kant op gaat. Het leest vlot en licht, zonder kinderachtig te worden. Ook voor een leeslijst werkt het goed, omdat het voelt als een verhaal en niet als huiswerk.
het en dat moment aat. Het leest vlot en



















Stel je voor: je bent veertien, je grootste zorg is normaal iets met huiswerk of een irritante docent, maar dan sta je ineens op de set van Stranger Things. Nell Fisher overkwam het. In seizoen 5 speelt ze Holly Wheeler, het kleine zusje van Mike en Nancy. De Brits-NieuwZeelandse Nell begon pas in 2022 met acteren en stond kort daarna al in films. Nu loopt ze rond op sets die miljoenen mensen al jaren kennen, met monsters, knipperende lampen en geheimzinnige scènes. Nell vertelde over die beginperiode: „Het was best doodeng,
y e Brits-Nieuw n 2 na set ke e Ne rio

Brits-Nieuw2022 met a al in ts die ennen, ell ode:

























Ohjijzt mijnwiskun jj een le j kijke eng' w dacht z eindelij natuurl van sei
OhjijzitinS nded euke en v was ze v jk w lijk j izo





maar iedereen was zó aardig dat ik er vanzelf in rolde.” Na een jaar draaien in Atlanta ging ze terug naar school. Je verwacht gegil op de gang, selfies, aandacht. Maar Nell merkte dat klasgenoten het eigenlijk nauwelijks boeit. Dus dan krijg je reacties van: OhjijzitinStrangerThings,oké,maar mijnwiskundedocentwasirritantvandaag. Nog een leuke: ze mocht de serie eerst niet kijken van haar moeder omdat het 'te eng' was. Toen ze auditie deed, dacht ze vooral: mooi, dan mag ik het eindelijk wél kijken. En dat deed ze natuurlijk ook, alles achter elkaar, van seizoen één tot en met vier.
































Uitgever: ImmunoWars (@immunowars)







Leeftijd: vanaf 16 jaar | Spelers: 2-6
ImmunoWars Base Game, Het Meest Besmettelijke Bordspel, is een strategisch kaartspel waarin je biowarfare voert op vrienden en vijanden. Je besmet elkaar met virussen en bacteriën. Je beschermt jezelf met hulpmiddelen, medicijnen en een sterk immuunsysteem. Anderen dwarsboom je met acties, zoals organen stelen, op iemand niezen of iemand in quarantaine zetten. Het is wetenschappelijk correct; de kleine details over al die virussen kloppen. Ook fijn, het spel is genadeloos. Dood is dood. Winnen draait om de juiste keuzes maken. Je hebt vijf opties en per beurt kies je er drie, met een beetje geluk erbij. Het is dus echt meer dan alleen 'leuk'. Het thema is strak uitgevoerd. Het thema is strak uitgevoerd. Weet wel dat er soms sprake is van donkere humor en er komen ook wat ongemakkelijke feitjes voorbij. Insta: boardgame_review_tanja








Score: ✪ ✪ ✪ ✪ ✪










Gek, Niks en Niemand zitten in een boom. Plots valt Niemand eruit. „Snel bel de ziekenwagen”, zegt Niks. Gek belt naar het ziekenhuis en zegt: Hallo ik ben Gek. Ik bel voor Niks. Want Niemand is uit de boom gevallen.



De woorden hieronder zitten in alle richtingen verstopt. Sommige letters kunnen vaker gebruikt worden. Streep alle woorden af die je hebt gevonden. De letters die overblijven, zet je achter elkaar in de lege hokjes. Dat is de oplossing.

BROEDMACHINE
DOOIER
EIEREN
EIWIT
GRIT
GROENVOER HOEN KAM

KIPPENREN

RAS SLAGPEN
SNAVEL STOK STRO WINDEI WORMEN ZAND







Deze grappige serie zit vol actie, humor en… geiten. Samen met haar geitenfamilie beleeft Gigi elke dag de wildste avonturen. Nu wacht haar grootste uitdaging: school overleven en menselijke vrienden maken. Te zien vanaf zaterdag 14 maart, elk weekend om 11.15 uur op Cartoon Network, en te streamen op HBO Max.




















DenD verloot een Cartoon Network-pakket! Stuur je oplossing van de woordzoeker in op ditjesendatjes.nl/puzzel om kans te maken.








vocht te koop

maar ook om me

DenD verloot Satijn Tricolor armband met 14 karaat goud! Stuur de oplossing van de puzzel in op ditjesendatjes.nl/ puzzel om kans te maken.
Deze satijnen armband met blauw koord en tricolor 14 karaat gouden details is juist zo leuk omdat hij klein en strak is. Subtiel om solo te dragen, maar ook perfect om te stapelen met je horloge of andere bandjes. De armband komt van Maxgoud (Admiraal de Ruyterweg 16a, Rotterdam), bekend van Daphne Roes uit de undercovertest van VARA Kassa, waar ze de hoogste goudprijs kreeg. maxgoud.com
De Trollbeads Geluksknoop-armband is zo’n sieraad dat het altijd goed doet. Strak, tijdloos en met een knoopje dat staat voor verbinding, kracht en een beetje mazzel. Hij is subtiel genoeg voor elke dag, maar net opvallend genoeg om wél gezien te worden. Past bij alles, van blazer tot hoodie. Leuk om cadeau te geven, nog leuker om zelf te houden.














oplossingarmbandweg.Stuurde vandepuzzelin op ditjesendatjes.nl/ puzzel om kans te maken.
Sir Winston Fun & Games heeft meerdere arcadehallen door heel Nederland. In elke vestiging vind je een indrukwekkend spel-aanbod, van behendigheidsspellen tot klassieke arcadegames. Je kunt er highscores neerzetten, tickets verzamelen en coole prijzen winnen. Ook kun je terecht voor toffe kinderfeestjes en bedrijfsuitjes die je volledig naar wens kunt samenstellen. Met locaties in Rijswijk, Schiedam, Scheveningen, Ypenburg, Amsterdam en Zaandam is er altijd een vestiging bij jou in de buurt. sirwinstonfungames.nl



WINNEN!
DenD verloot een Sir Winston Fun & Games-prijs met drie gymtassen, 60 tickets (voor de spellen/prijzenmuur), drie knuffeldiertjes en 30 minuten gratis gamen voor drie personen. Stuur de oplossing van de puzzel in op ditjesendatjes.nl/puzzel om kans te maken.















Ook De 538 Ochtendshow komt in deze periode in actie voor het Máxima.

Ieder jaar krijgen ongeveer 600 kinderen in Nederland de diagnose kanker. Helaas overlijden twee tot drie kinderen per week aan deze ziekte. Daarom is de missie van het Prinses Máxima Centrum voor kinderoncologie: ieder kind met kanker genezen, met een optimale kwaliteit van leven. Kom in actie voor deze missie door je statiegeldbon(nen) tijdens deze actieperiode te doneren aan het Máxima.
Ook De 538 Ochtendshow komt in deze periode in actie voor het Máxima. Op zaterdag 14 maart vindt voor de derde keer De 538 Ochtendrun plaats in het Olympisch Stadion in Amsterdam. Luisteraars, gezinnen, ambassadeurs, de dj’s én Dirk-medewerkers doen mee aan de run van 5,38 kilometer om zoveel mogelijk geld op te halen voor het Máxima. De statiegeldactie van Dirk draagt bij aan De 538 Ochtendrun voor het Máxima. Voor een kind met kanker is een
tijdige diagnose van levensbelang. Hoe sneller duidelijk is om welk type tumor het gaat, hoe eerder de best mogelijke behandeling op maat kan starten, met zo min mogelijk bijwerkingen.
Daarom gaat de opbrengst van De 538
Ochtendrun 2026 én de statiegeldactie van Dirk naar drie innovatieve technologieën waarmee sneller en nauwkeuriger kan worden vastgesteld om welk tumortype het gaat. Zo wordt de onzekere periode tot de diagnose verkort en neemt de kans op genezing toe, met de best passende behandeling voor ieder kind. ■
Steun het Máxima door tussen 2 maart en 14 april je statiegeldbon(nen) te doneren bij het flesseninleverpunt in jouw Dirk-winkel.





























Onze haringpartjes in kerriesaus zijn zacht, licht pittig en verrassend lekker. Een smaakcombinatie die je geproefd móét hebben.
















GROLSCH 0.0


Grolsch 0.0% is verfrissend en vol van smaak. Gebrouwen met dezelfde toewijding als ons Premium Pilsner, maar dan zonder alcohol. In 2025 uitgeroepen tot het beste 0.0 bier van Nederland. Proef ’t zelf.





DenD en Oranje Boven zijn de grootste gratis redactioneel onafhankelijke familiebladen van Nederland met een oplage van 650.000 exemplaren. Gratis meenemen bij de meer dan 130 supermarkten van Dirk van den Broek en 44 Dirck3-slijterijen.
Ga naar www.dend.nl voor het actuele entertainment- en royaltynieuws.
Uitgever
Brookland Productions, Sassenheim
Concept, realisatie en redactie
Trusted Media Publishers
Fotografie





















Johannes Dalhuijsen, ANP/ Hollandse Hoogte o.a.: Edwin Jansen, Anneke Jansen, Patrick Harderwijk en Robin Utrecht, Flickr, Unsplash, Instagram, Facebook, Netflix, Jurjen Donkers
Adres redactie DenD
Trusted Media Publishers
Donauweg 10 1043 AJ Amsterdam
DenD wordt verspreid via: alle Dirk van den Broek-supermarkten en Dirck3-slijterijen
Niets in deze uitgave mag, in welke vorm en op welke wijze dan ook, worden overgenomen zonder voorafgaande schriftelijke toestemming van de uitgever. Hoewel DenD met de grootst mogelijke zorgvuldigheid wordt samengesteld, staan uitgever en redactie niet in voor eventuele onvolkomenheden in de inhoud en kunnen hiervoor niet aansprakelijk worden gesteld. Niet alle in de advertenties genoemde producten zijn verkrijgbaar in de winkels die hieronder worden genoemd.
Caudalie: nl.caudalie.com
Jlab: jlab.com
Hema: hema.nl Marie-stella-Maris: mariestellamaris.com
Secrid: secrid.com/nl
Zenner: zenner.eu/nl
























































GET THE MOST OUT OF EACH RUN! LIFE IS YOUR PLAYGROUND




















